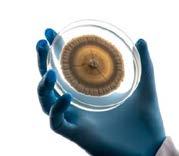

By Fiona Gowers
In a world-first, Australian scientists have discovered specific fungi that help to significantly reduce methane emissions from livestock, offering a breakthrough solution for agriculture to cut emissions.
The discovery provides livestock producers with a naturally-derived, scientifically-validated



feed additive that can be integrated into existing operations and supply chains to drive methane reduction at scale.
Discovered by Loam Bio’s Dr Abed Chaudhury - with validation and research and development led by Matthew Callaghan - this breakthrough was enabled by Loam Bio’s extensive library of soil fungi.
In Dr Chaudhury’s research across a wide
range of fungi, he found that a very small selection of naturally-occurring species in the US and Australia have both the genetic capability and expression required to significantly cut methane produced by livestock.
“This is a true breakthrough and an exciting moment in microbiology to make such a profound discovery,” he said.
COVERAGE PAGES 2-3
Incredulous and furious Queensland pastoralists have united to oppose a big push to list buffel as a weed.
Beef producers covet the controversial yet critical grass as it provides fast-growing cattle fodder and can help reduce dust and soil erosion.
Environmental and Indigenous groups, however, have long warned it exacerbates grass fires, reduces biodiversity and impacts Aboriginal cultural practices.
AgForce Queensland Cattle president Lloyd Hick said classifying buffel as a weed would have “severe“ consequences for Queensland’s beef industry, including biological control research aimed at eradication.
“This is a direct threat to one of the most critical pasture species in Australia,“ he said.
COVERAGE PAGES 4-5
Matthew Pearce of GDL Emerald has been crowned the 2025 National Young Auctioneers’ champion at the Sydney Royal Easter Show.
Mr Pearce’s slick marketing skills saw him sell the competition’s top-priced steer for $15.90/kg, which helped him to clinch victory on April 10. Overwhelmed as he received the trophy from the Australian Livestock and Property Agents Association (ALPA), Mr Pearce, 23, thanked his family, ALPA, sponsors, buyers, underbidders and GDL for their support.
He will now represent Australia at the International Livestock Auctioneer Championships at the 2026 Calgary Stampede. STORY PAGE 6



BUFFEL BATTLE pages 4-5
YOUNG AUCTIONEER page 6
RODEO LEGACY page 8
AGFORCE COLUMN page 10
WOMEN IN AGRICULTURE pages 18-19
TOOWOOMBA SHOW pages 20-24
FARMFEST 50 YEARS pages 28-29
MARKET ROUND-UP page 31
SPORT pages 33-36
Queensland Farmer Today’s FIONA GOWERS spoke to ROAM Agricultural COO Matthew Callaghan about the remarkable ability of fungi to lower methane emissions from livestock.
1) What is the strain of fungi being used? The fungal strain we are using naturally occurs in the soil and belongs to the Curvularia genus. ROAM’s parent company Loam Bio has a vast microbial library. We used this library to identify the small number of naturally occurring fungal strains that have the genetic capacity to produce anti-methanogenic compounds. We then verified this capacity by culturing the fungal strains in the lab and optimised their growth. The culturing process is highly scalable, fast and very high yielding.
2) Why are methane emissions from livestock so concerning?
Methane is a byproduct of naturally digestive processes in cattle, sheep and goats. It is a large source of greenhouse gas emissions within agriculture in Australia. It is a potent greenhouse gas but luckily it only has a short life of approximately 12 years in the atmosphere. That means efforts to lower methane emissions from livestock can have beneficial effects in a relatively short time. It is also important to recognise that the livestock industry is vital to food production, rural economies and national exports. We aim to empower producers. ROAM’s solution gives farmers a naturally-derived, science-based tool to meaningfully reduce emissions without compromising productivity or profit. It is about
Address: 154-156 Haly Street
Kingaroy 4610
Telephone: 07 4182 0450
Website: QueenslandFarmerToday.com.au
CONTACT US
Editorial:
Email: newsdesk@QueenslandFarmerToday. com.au
Advertising: Email: advertising@QueenslandFarmerToday. com.au
Classifieds:
Phone: 07 4182 0450 or 1300 666 808
Email: sales@networkclassifieds.com.au
EDITORIAL
Fiona Gowers Editor
E: fiona.gowers@QueenslandFarmerToday.com.au
Breanna Lloyd Journalist
E: breanna.lloyd@QueenslandFarmerToday.com.au
ADVERTISING
Samantha Wantling Sales & Marketing
E: samantha.wantling@WarwickStanthorpetoday.com.
au P: 0439 420 289
Jane Lowe Sales & Marketing
E: jane.lowe@QueenslandFarmerToday.com.au
P: 0408 488 609
Jemma Wilson Sales & Marketing
E: jemma.wilson@BurnettToday.com.au
P: 07 4182 0458
Nicola Rickuss Sales & Marketing
E: nicola.rickuss@TodayNewsGroup.com.au
Queensland Farmer Today is published monthly and part of the Today News Group. Published by South Burnett Today Pty Ltd ACN
Publisher:

future proofing the industry while maintaining its economic strength and giving the consumer what they want, which is a naturally derived solution.
3) When will this product be available for Queensland farmers to access?
We are aiming for limited commercial availability within the next 20 to 24 months, with research trials already underway. Our focus is on proving performance in both intensive feedlot systems and extensive grazing operations common in northern Australia. We have been working with CSIRO in Townsville to test the product in their methane chambers and have worked with QUT

With the Federal Election set for 3 May , it is crucial that all Members of Parliament and Senators prioritise the needs of rural Australia and step up to secure a healthier future for all Australians, according to the National Rural Health Alliance.
The Alliance is made up of 53 national organisations committed to improving the health and well-being of the more than seven million people in rural and remote Australia.
Members include representation from health professional organisations, health service providers, health educators, the Aboriginal and Torres Strait Islander health sector and students.
Alliance chief executive officer Susi Tegen said as the cost of living continued to rise, the disparities in healthcare funding and access for rural people were becoming more pronounced, making it vital for this election to focus on ensuring health equity for all Australians.
Ms Tegen said rural Australians made up 30 per cent of Australia’s population, contributing significantly to the economy, and generating 70 per cent of export income through industries, such as agriculture, minerals, tourism, retail, services, and manufacturing. They also account for 50 per cent of the nation’s tourism income and provide 90 per cent of the country’s food.
“We urge all Australians and the candidates who seek their votes to recognise and address the healthcare challenges and earlier deaths that persist in rural areas, ultimately impacting all Australians.
“We ask for their support to implement a National Rural Health Strategy to coordinate Com-
monwealth, State, and Territory policy, investment and service delivery.
“This will ensure grassroots-led, sustainable solutions for rural communities throughout the patient journey,” Ms Tegen said.
“We have heard from individuals who must travel hundreds of kilometres to access basic care, as the services have disappeared, and no one seems to care.
“Clinicians, no matter which health profession, are working many hours on the ground, are burnt out and feel unsupported.
“The solutions have been provided for any government to take up the challenge to be more flexible and focus on equity and reflect that we are all Australians.”
The Alliance is also calling for a $1 billion National Rural Health Fund, half of which should be to support blended or block healthcare delivery payments for where there is no or little access for populations to healthcare.
The other half would be put towards infrastructure for student, trainee or visiting clinician accommodation, outreach in infrastructure for service delivery, or for childcare.
This would help address the critical shortage of healthcare professionals in rural regions.
“It is time for all political leaders to step up, commit to the 7.3 million rural people that they would implement long-term solutions, and ensure that no Australian, no matter what their postcode, is left behind when it comes to accessing quality health care,” Ms Tegen said.
in Brisbane on experiments to refine our biomanufacturing process.
4) What do you envisage the cost will be?
Exact pricing is still being finalised whilst we scale up, but our goal is to keep the cost affordable and competitive with competitive anti-methanogenic compounds. Because our production method is scalable, extremely high yielding and does not rely on synthetic compounds or ocean harvesting, we are confident it will be cost effective, particularly when factoring in potential for productivity gains and future carbon market incentives.
In 2005, a national issue I initiated through The Land newspaper was the loss of maternity services in rural Australia and its effect on regional communities. Headed Labour Pains, this four-part series highlighted the challenges of attracting medicos to the bush and, through the advice of practising obstetricians, how best to reverse the decline.
It is staggering then that 20 years lateron World Health Day (7 April) - the Australian College of Rural and Remote Medicine (ACRRM) is still urging all political parties to prioritise maternity care in their election commitments, ensuring women in rural and remote communities can access safe, high-quality care close to home.
As while Australia’s healthcare system ranks among the best in the world, rural, remote and First Nations women face increasing barriers to maternity care as services are closed or downgraded, forcing them to travel long distances and putting their and their babies’ health at risk.
Recent data from the Australian Institute of Health and Welfare shows that nearly 80,000 women give birth outside major cities each year.
ACRRM president Dr Rod Martin said while there was growing political recognition of women’s health, a clear plan to reverse the decline of rural maternity services did not exist.
“We’ve recently seen rural and remote maternity units close or downgrade across services in Far North Queensland, New South Wales and Tasmania,“ he said.
“Every closure makes it harder for women who are most in need to access safe, affordable care.
“We cannot wait for a tragedy to spur action. This election is a critical moment.
“We need all parties to commit to sustainable, high-quality maternity care for rural and First Nations communities — because no mother or baby should face greater risks simply because of where they live.”
Yes, indeed.
- Fiona Gowers


Weanersgrazesub-tropicalpasturesinsouth-eastQueensland.
Aplateoffungiusedforreducingmethanein ruminants.

AnguscattleatTalinga,Woodstock,NSW.
By Fiona Gowers
In a world-first, Australian scientists have discovered specific fungi that help to significantly reduce methane emissions from livestock, offering a breakthrough solution for agriculture to cut emissions.
The discovery provides livestock producers with a naturally-derived, scientifically-validated feed additive that can be integrated into existing operations and supply chains to drive methane reduction at scale.
Discovered by Loam Bio’s Dr Abed Chaudhury - with validation and research and development led by Matthew Callaghan - this breakthrough was enabled by Loam Bio’s extensive library of soil fungi.
In Dr Chaudhury’s research across a wide range of fungi, he found that a very small selection of naturally-occurring species in the US and Australia have both the genetic capability and expression required to significantly cut methane produced by livestock.
“This is a true breakthrough and an exciting moment in microbiology to make such a profound discovery,“ he said.
“With this finding, I believe it to be imminently achievable to accelerate the way we offer agriculture the pathways to cut greenhouse gas emissions.
“Fungi make this possible in an elegant and highly scalable way.”
Supported by the Australian Government’s Methane Reduction in Livestock (MERiL) program, the research has paved the way for a dedicated spin-off from Loam Bio, called ROAM Agricultural.
This independent venture will drive the commercial impact of this naturally-occurring, fungal-derived technology, establishing ROAM as a market leader in climate tech solutions while complementing Loam Bio’s groundbreaking work in carbon sequestration.
ROAM Agricultural CEO Derek Peterson said the breakthrough would provide the livestock industry, which is essential for feeding the global population, with the right set of tools to mitigate enteric methane emissions.
“ROAM’s proprietary naturally-occurring,


ROAM’sfermentationscientistHopPhaninspectsabioreactorgrowingthemethanebustingfungi. (Supplied)
non-GMO fungal-based methane reduction technology has been developed for seamless integration into existing livestock management practices,“ he said.
“Leveraging our patent-pending innovation, a facility no larger than a microbrewery can efficiently produce enough to supply a significant proportion of Australia’s national herd.“
The scientific breakthrough has been independently validated through a peer-reviewed publication, demonstrating that fungal-derived feed additive technology can reduce livestock methane by 90 per cent as cited in Biotechnology Reports.
Research Professor Dr Zoey Durmic from the University of Western Australia AgGHG Research

Hub, has been involved in the initial testing in an artificial rumen using fungal extracts from the new technology.
“In early stage testing, the fungal extracts had considerable impact on reducing methane, including almost complete inhibition, without having negative impacts on rumen fermentation characteristics,“ Dr Durmic said.
“While the efficacy may reduce under less controlled conditions, we are excited about the potential of this to translate into high levels of methane reduction in trials with livestock under a variety of diets and production systems.”
Loam Bio co-founder and COO Tegan Nock said there was untapped potential for fungi to deliver practical solutions to some of the world’s big



ROAM’santimethanogeniccompound,stabilised onadry,foodgradecarrier.
challenges and Loam Bio is providing the pathway for these discoveries to be made and commercialised.
“We use Loam’s rich microbial library, combined with our proprietary bioinformatics platform, to create impactful global climate solutions.
“Loam’s focus is on our products that sequester and stabilise carbon in agricultural soils, our R and D platform holds enormous value, demonstrated here by the discovery of a fungal solution for methane.
“We are proud to now spin out ROAM Agricultural to commercialise this fungal technology, for scalable impact for agriculture and our food system.”


By Lloyd Hick, Agforce Cattle Board President
Buffel grass is facing an existential threat. The push to list it as a Weed of National Significance (WoNS) would have severe consequences for Queensland’s beef industry and broader agriculture. If listed, buffel could face legislative restrictions, removal requirements and even biological control research aimed at eradicating it. This is a direct threat to one of the most critical pasture species in Australia.
The process has been anything but transparent — there is no confirmation on who has nominated buffel and there is no formal appeal mechanism once a species is listed. A decision with such far-reaching consequences cannot be made behind closed doors.
Buffel is not a weed. It is the backbone of Queensland’s grazing systems. It sustains the production of millions of kilograms of beef that underpin domestic and international food security. Removing access to buffel would cripple the beef industry. Restricting seed supply would undermine pasture regeneration and any move towards biological control would be catastrophic for entire grazing regions. The economic damage would be widespread yet and, most critically, the nomination process fails to consider the production and financial consequences of its removal.
The determination process is fundamentally flawed. The Weeds of National Significance assessment only accounts for a plant’s negative environmental impact, completely disregarding its role in agriculture and broader food security. The consequences are permanent, no matter the cost to producers.
Buffelalsoplaysavitalroleinlandscapeprotection. It prevents soil erosion, reduces dust storms and regenerates quickly after fire. At a time when sustainability reporting is becoming more complex, a WoNS listing would add unnecessary compliance burdens, affecting market access, financial approvals and long-term property viability.
This is not an isolated issue. It is part of a broader pattern of decisions being made without

industry input, with disastrous consequences for agriculture. If the beef sector does not push back hard on this, it will be taken as a win and another critical pillar targeted next.
This is a fight for the future of Queensland’s beef industry. AgForce is taking the lead but this fight requires the full force of industry. We need producers to stand with us and act when needed
to ensure this doesn’t go unchallenged. Government and industry bodies must hear from all corners of the cattle sector — this cannot be ignored. The industry must show that it will not allow
Flood-affected soybean farmers in northern NSW and north Queensland say the best way concerned Australians can help farmers is at the supermarket checkout.
Casino soybean grower Paul Fleming said offers of help his region had received were “moving“ following major crop losses in the Northern Rivers region of New South Wales.
“Our district has only just begun to recover from the devastation of the 2022 floods,“ he said. “So to be hit by floods again within three years has really knocked us around.“
Mr Fleming has heard reports of destroyed and damaged soybean crops throughout the district and says the best way consumers can help growers recover is to buy Aussie grown when they shop.
“People wanting to help can support Aussie soybean growers by making sure they put Aussie grown soybean products in their shopping trolley,” he said.
Mr Fleming, a board member of Soy Australia, said he believed most people were unaware that most soy-based foods in the supermarket were made with soy ingredients imported from places like China.
“If consumers choose brands that support Aussie farmers they can make a huge difference to local soybean growers and help us keep afloat during difficult times,” he said.
“Companies like Vitasoy, for example, buy a lot of soybeans from the Northern Rivers and
exclusively use Aussie-grown soybeans in their soy milk and yoghurt range.“
“In fact, Vitasoy are the only Aussie soy milk manufacturer using Aussie-grown soybeans in their milk. Other brands use clever marketing to stop consumers realising they actually use imported soy in their milks.
“When you see wording like ’Made in Australia with 99 per cent Australian ingredients’ on your soy milk, then you can be confident that company is supporting Aussie farmers.
“The same goes for soy-based foods like tofu or tempeh.
“The ingredient list should be virtually 100pc Aussie.“
For North Queensland soybean grower
Christian Lago said it had been a season of constant weather challenges and lots of uncertainty.
“Our soybean season in the Burdekin region has been a challenge from the start,“ he said.
“Before Christmas we were struggling to get soybeans in the ground thanks to wet weather and a delayed cane harvest and, then, the paddocks we did plant have been through flooding rains in early February followed by more heavy rainfall in late March.
“We’ve got about four weeks to go before we harvest and, to be honest, there’s a lot of uncertainty whether our soybeans will make it into the silo thanks to the vagaries of the weather.“

• Soften hard water for decades on $10 power yearly
• Clear out scaled pipes, increase flows
• More effective than magnets by design
• Grow healthy plants using saline water
• Healthy stock using hard water
• No waste streams or decreases in flow
• Used by farmers, stations, councils, mining companies
• Scientifically tested and proven technology
• Australian Made and Owned for 23 years

By Fiona Gowers
Incredulous and furious Queensland pastoralists have united to oppose a big push to list buffel as a weed.
Beef producers covet the controversial yet critical grass as it provides fast-growing cattle fodder and can help reduce dust and soil erosion.
Environmental and Indigenous groups, however, have long warned it exacerbates grass fires, reduces biodiversity and impacts Aboriginal cultural practices.
AgForce Queensland Cattle president Lloyd Hick said classifying buffel as a weed would have “severe“ consequences for Queensland’s beef industry, including biological control research aimed at eradication.
“This is a direct threat to one of the most critical pasture species in Australia,“ he said.
Jacqueline Curley, Gipsy Plains Brahmans, Cloncurry said in the COWMAB against CACTI Facebook group:
“This is an issue every livestock producer needs to address … now.
“The time for sitting on hands and letting someone else do the hard yards of saving industry standards is over.
“This is a very, very serious issue that will not be fixed once the horse has bolted.
“Northern Territory and South Australia did not address it well. It is on their noxious weed list (since 2024 and 2019 respectively) and they will suffer the consequences of lost production.
“Queensland has some time left to address the issue.“
Ian McCamley, MCC Pastoral Pty Ltd, Rolleston, meanwhile, said in the COWMAB against CACTI Facebook group:
“I believe when one really thinks about it, Australia rides on the back of buffel grass. It beggars belief that there are people in Australia lobbying for a biological control for buffel.
“Rural communities would be decimated if we lost the productivity that can be directly attributed to buffel grass.
“Of course, with beef being such a critical export income earner, the economic loss would be felt across all of Australia.
“Of equal importance would be the massive environmental damage caused by the loss of buffel.
“My 45 years of self-funded research clearly shows that ground cover is the most critical thing to maintaining a healthy productive sustainable environment.
“By taking buffel grass out of the Australian environment, soil erosion would dramatically increase, rainfall would be lost to runoff rather than infiltrate as it does in a buffel pasture, evaporation would be unchecked, other plants, animals, birdlife and insects would be at huge risk with the ecosystem regression that would result.
Kennedy MP Bob Katter pleaded for common sense to prevail.
“They want to list buffel grass as a weed. Give us a break! The north was built on buffel, Brahman, and bitumen—without it, we’d have a dust bowl instead of a cattle industry.
“Buffel grass wasn’t brought here by accident – it was introduced because it’s one of the best options we’ve got. It holds the soil together and

keeps the cattle fed even during drought.
“Meanwhile, real pests like lantana, prickly acacia, rubber vine, feral pigs and cats are running wild — and the government wants to waste time attacking one of our best pasture grasses?
“Sometimes, you’ve got to wonder if these ’green’ groups, whose bidding the government is doing here, won’t stop until our entire agricultural industry is dead and we import everything into this country.
“This is anti-livestock ideology at its worst. Anyone pushing this nonsense needs their head read.“
Cattle Australia (CA) chief executive Dr Chris Parker said calls from environmental lobbyists to have it listed as a weed ignored the incredible contribution buffel grass has made to the economic viability and sustainability of the Australian beef industry.
Indeed, regional and rural Australia as a whole.
“It is a flawed ideology for buffel grass to be considered a weed of national significance when it has positive environmental, social and economic impacts for Australia and is absolutely vital for Australia’s agricultural and livestock industries,“ Dr Parker said.
“Buffel grass shares no characteristics with actual weeds of national significance.
“When compared to the environmental impact of lantana or blackberries, buffel grass should not even be in the same conversation.
“It is essential to the production of millions of kilograms of beef for Australian and international markets.
“In 2024, Australia exported 1,972,000 tonnes (carcass weight) of beef and the red meat supply chain employed more than 430,000 people, contributing tens of billions of dollars to the national



economy and buffel grass has been critical to that success.
“It is clear there needs to be an urgent reform of the process used to assess the impact of nonnative plant species, to ensure plant species of
economic and agronomic significance are not targeted.
“And, immediate action should be taken to establish buffel grass as a Primary Production Strategic Asset.”


By Fiona Gowers
Matthew Pearce of GDL Emerald has been crowned the 2025 National Young Auctioneers’ champion at the Sydney Royal Easter Show.
Runner up was Austin Gerhardy from Nutrien Ag Solutions, Busselton WA.
Mr Pearce’s slick marketing skills saw him sell the competition’s top-priced steer for $15.90/kg, which helped him to clinch victory on April 10.
Overwhelmed as he received the trophy from the Australian Livestock and Property Agents Association (ALPA), Mr Pearce, 23, thanked his family, ALPA, sponsors, buyers, underbidders and GDL for their support.
He will now represent Australia at the International Livestock Auctioneer Championships at the 2026 Calgary Stampede.
Raised between his parent’s 12-hectare block in Gympie and his grandparent’s 1618ha mixed-farm at Cinnabar, Mr Pearce said winning was a dream come true.
“Yeah no, I don’t really have any words for it,“ he said.
“I’ve always wanted to do it and there’s a lot of people on that trophy that have achieved great things in their careers.
“They are great blokes and great for the industry.“
Hosted ALPA, this year’s competition boasted nine finalists from across the country; two from Queensland, New South Wales, South Australia and Victoria and one from Western Australia.
Queensland - represented by Mr Pearce and Dustyn Fitzgerald, Nutrien Ag Solutions, Dalbyachieved the highest aggregate score to claim the NAB Agribusiness Team Shield.
Mr Pearce has worked as a stock and station agent for five years.
After graduating from St Patrick’s College in Gympie, he worked for Sullivan Livestock and Rural Services in Gympie before shifting to GDL in 2021, firstly based in Rockhampton and then Emerald from 2023.
He sells weekly at the prime and store sales in Emerald “and the occasional stud sale“.
“What I enjoy most about the job is drafting cattle and selling cattle on the rail,“ Mr Pearce said.
“Selling the cattle for as much as you can is a good feeling. As is seeing the smiles on clients’ faces.
“My plans for the future are to keep growing my business and keep furthering my client base.“
National Finalists
New South Wales finalists:
• Jaiden Burke, Nutrien Ag Solutions, Wagga Wagga
• Darcy Howard, MCC Howard Oliver, Cowra Queensland finalists:
• Dustyn Fitzgerald, Nutrien Ag Solutions, Dalby
• Matthew Pearce, GDL Rural, Emerald
South Australia finalists:
• Jack Guy, Spence Dix & Co, Keith
• Josh Pahl, Southern Australian Livestock, Naracoorte
Victoria finalists:
• Declan Haines, Elders Rural Services, Ballarat
• Will Holt, McKean McGregor, Bendigo
Western Australia finalist:
• Austin Gerhardy, Nutrien Ag Solutions, Busselton
New South Wales finalists:
• Adam Boyd, Elders Rural Services, Wagga Wagga
• Darcy Brennan, Lehman Stock & Property, Inverell
• Ryan Carpenter, Nutrien Ag Solutions, Bathurst
• Joshua Fenech, Jim Hindmarsh & Son, Moss Vale
• Will McLachlan, Elders Rural Services, Wagga Wagga
• Michael Purtle, Purtle Plevey Agencies, Manilla
• Luke Richards, JA McGregor Livestock & Property, Warialda
• Sam Thomas, Nutrien Milling Thomas, Dubbo
• Jack Whitty, Kevin Miller Whitty Lennon & Co, Forbes.


Kingsthorpe


A US breeder has purchased the exclusive American semen rights for the current Australian record price Santa Gertrudis bull Yarrawonga Spartacus S316 (P), owned by NIOA Santa Gertrudis (7/8th share) and RL Pastoral Company (1/8th share).
The landmark deal will see Yarrawonga Spartacus’s bloodlines incorporated into Texasbased Ellis Pastures’ breeding program.
The deal, brokered by NIOA’s annual sale strategic partner RL Pastoral Co’s Rob Sinnamon for an undisclosed six-figure sum, has been described as a game changer for the US Santa Gertrudis industry.
“We are happy to be working with NIOA and RL Pastoral Company on this opportunity,” said Saenger Ellis, owner of Ellis Pastures.
“Securing genetics from a bull of Spartacus’ calibre is a game changer for the US Santa Gertrudis industry.
“His outstanding phenotype, structural correctness, and genetic potential will be a tremendous asset to American breeders looking to enhance their herds.”
Spartacus was introduced to the Allora-based NIOA stud’s sire battery in November 2022 after NIOA paid an Australian record breed price of $250,000 at the Bassingthwaighte family’s Yarrawonga Santa Gertrudis annual sale.
He is the grandson of 2014 Brisbane Ekka Grand Champion Yarrawonga Corvette H730 (P), described as “without doubt, the best bull that Yarrawonga has produced”.
And with more than 140 calves on the ground through natural service, artificial insemination, and IVF, his offspring are demonstrating the quality traits their bloodline is renowned for - growth rate, temperament, fertility, consistency and adaptability.
“Spartacus represents the modern-day Santa Gertrudis bull,” said Mr Sinnamon. “He combines the breed’s most desirable characteristics with flawless structure, tremendous volume, and body capacity.

“His genetic potential meets a wide range of market specifications, making him a valuable asset globally. To be selling genetics in an American breed back to American breeders demonstrates
just how exceptional this bull is.”
NIOA Santa Gertrudis General Manager Shannon Gardner said: “Spartacus has already proven his worth here and we have no doubt his influ-
/ 9.5












By Breanna Lloyd
The news about Ray Hermann getting his own statue in Winton travelled far and wide.
One of Ray’s mates is Roslyn Lindsay, the wife of the late country music star Reg Lindsay.
Roslyn first met the iconic “Winton Whiz“ in the early 80s when she began competing on the circuit.
“Ray is one of the nicest and funniest blokes I’ve ever met,” she said.
“Ray is a one-of-a-kind bloke and an icon. He’s a gentleman and a true Aussie.
“Ray is a very accommodating person, and it was so much fun to do rodeos and events at the same time with him.
“Some of the stories Ray would come out with were hilarious.
“The statue is a huge honour and well deserved for Ray, and I couldn’t be happier for him.”
After Reg met Ray during a rodeo event, he decided to put his musical talent toward creating a song for the rodeo champion.
Following their marriage in 1988, Roslyn and Reg headed into a Sydney music studio to produce the song.
Within three days of writing, singing, and recording, the 45 single was complete.
“Reg really liked Ray and thought the song was an opportunity to celebrate Australia’s best saddle bronc champion,” Roslyn said.
“Reg loved the idea of cowboys and rodeos, so incorporating Ray into a country-themed song was brilliant.
“Ray didn’t know about the song until we sent 45 singles to his doorstep.
“When he saw them, he laughed. I think he was in shock but very happy that we had done that.”
When Roslyn slowed down with her rodeo career, she shifted her focus to producing music with Reg.
After a 50-year-long career in the spotlight, Reg passed away in 2008, shocking Australian country music fans and leaving Roslyn to navigate life without him.
Now, many years have passed since she last saw Ray, and Roslyn says she misses the “good ol’ days“ when they would all attend rodeos together.
“A funny story I still remember was when Ray, a few others, and I would hop into a single-engine propeller plane to travel to different rodeos in Tasmania,” Roslyn said.
“Ray and I would sit in the back with the pilot’s son.
“This one time the plan ended up being too heavy, so for take-off, we all had to lean forward to help the plane lift off the ground.”
Now based in Tamworth, New South Wales, Roslyn manages Reg Lindsay Promotions, promoting his music and memorabilia, as well as the Reg Lindsay and Friends Museum, where a lifesized statue of Reg stands in tribute.


Reflecting on her husband’s statue, Roslyn said she couldn’t be more excited for Ray, calling his upcoming recognition a fantastic initiative and a fitting honour for the Winton Shire.
“I think it’s a fantastic initiative, and it’s well deserved for Ray,” she said.
“I would love to catch up with Ray, have a rum, and reminisce about the good old days.”

With the introduction of two new high-yield varieties Brolga and Kookaburra, Queensland’s mungbean industry is set for a significant boost.
The varieties were developed through the National Mungbean Improvement Program (NMIP) - a co-investment between the Department of Primary Industries (DPI) and the Grains Research and Development Corporation (GRDC) - and were developed to provide growers with improved grain quality and disease resistance.
The varieties were officially launched last month at the Hermitage Research Facility in Warwick, with co-funders DPI and GRDC and commercial partner Australian Mungbean Association (AMA).
The launch brought growers and stakeholders into the field to examine and contrast the new lines with existing varieties, highlighting DPI’s scientific contributions to the industry.
The joint $8.3 million GRDC-DPI National Mungbean Improvement Program has been running since 2022 and is a modern and efficient breeding initiative focused on developing

varieties that support consistent production, underpinning enduring profitability for growers.
Queensland’s mungbean industry will generate more than $113 million in export revenue in 2023 and 2024, making it an important export crop.
The introduction of these superior varieties is expected to further cement Queensland’s position as the leading supplier of premium
mungbean to international markets.
“These new varieties will help Australia meet its production target of 100,000 tonnes per year,” DPI principal plant breeder Dr Merrill Ryan said.
“With higher yields, larger seed size and resistance to halo blight, tan spot and powdery mildew, Brolga and Kookaburra will deliver immediate and lasting benefits to growers, processors and exporters.
“These new lines will enhance the stability of supply, ensuring Queensland continues to meet the growing global demand for high-quality pulses.”
Seed for these new varieties will be available for growers to purchase later this year for the summer 2026 growing season.
“Brolga and Kookaburra have the potential to improve grower returns while also enhancing Australia’s strong reputation as a premium supplier of high-quality, large seeded, green shiny mungbeans into high-value international markets,” Australian Mungbean Association president James Hunt said.
“The AMA is pleased to be the commercialising partner and looks forward to making these varieties available to growers in the 2025/2026 season through our member network.”
GRDC genetic technologies officer Dr Temitope Jekayinoluwa said the National Mungbean Improvement Program had opened new avenues for growers to boost their productivity and profitability.
“This is the fifth iteration of the NMIP, building on the achievements of previous investments in this field,” Dr Jekayinoluwa said.
“The initiative aims to develop and release varieties that have shown superior performance in regional yield trials and disease nurseries across the Northern Grains Region.
“It targets higher yields, consistency, adaptability and disease resistance, while also ensuring grain quality that meets premium international market standards.
“This latest launch is a prime example of the significant advancements this project continues to make for the industry.“
With some 70 per cent of Australian family farms expected to transition to the next generation within five years, a key event last month united bright young minds to identify gaps and opportunities to support young farmers.
The Future Farming Forum - hosted by Cotton Australia, RB Sellars and the Future Farmers’ Network - brought together more than 30 young Darling Downs cotton farmers to discuss their challenges, opportunities and training needs.
A highlight was an intergenerational transition session, which allowed for raw examination of the issues associated with transition planning for family farms.
Workshop facilitator Claudia Mitchell said the event was powerful because it led to the discovery of key challenges and skill gaps.
“The gold happened when trust was established in the room, allowing participants to be vulnerable about what they were experiencing on their own farms,“ she said.
“Being on farm can be isolating, resulting in tunnel vision so it’s good for growers to step back and connect with people of their own ages from other businesses.
“The feedback was raw and the peer-to-peer learning resulted in practical conversations and admissions of the difficulties in family transition planning and in running a family farm successfully.”
The key gaps identified were:
• Business management skills and training,
• Communication skills and methods, particularly intra-family, and
• People skills, including having difficult conversations, leading teams and managing people.
The group discussed key strategies and processes to help businesses maintain open communication and preserve relationships. They included regular meetings, technology to enable connection, clear chains of command and the ability to compromise.

Darling Downs grower David Walton was well placed to add value to the workshop having gone through intergenerational change over the past five years.
“Everyone goes through the same challenges with siblings not knowing what’s fair and what’s equal,“ he said.
“Then there’s partners of siblings and their children and unless there’s good communication and people are talking openly it can create real problems within families.“
David said an outside facilitator was the key to their success in the transfer of the farm from the parents to the children.
“Getting someone external takes the emotion out of the equation because someone is looking at the whole situation from the outside, communicating and assigning tasks to move forward.”
Cotton Australia CEO Adam Kay, who was at the workshop, said the peak body for growers would take whatever action it can to help.
“It’s clear some growers are looking for business planning and interpersonal skills and we have done a lot of work through Smart Ag Queensland so we will be looking for courses to help with these key areas,“ he said.
“I’m sure we are going to be able to deliver for these growers by guiding where the training goes next.”
Another of the participants, Goondiwindi grower Grace Griffith – a graduate of the Future Cotton Leaders Program – said the Cotton Australia and CRDC program had helped her improve her business management and communication skills.
“Future Cotton Leaders gave me new skills and confidence and has helped our family business,“ she said.
“It has also enhanced my leadership ability, leaving me confident to contribute on boards and committees and, in doing so, I feel I am giving back and helping other young farmers.”

By Fiona Gowers
Both sides of government must “put their money where their mouths are“ in response to Prime Minister Anthony Albanese’s ’Buy Australian’ call, according to Lockyer Valley Foods CEO Colin Dorber.
Lockyer Valley Foods is a proposed circular economy food and vegetable processing facility in Queensland.
Mr Dorber is calling on the federal government to . . .
• Substantially increase its commitment to the ‘Feeding Australia’ policy, and
• Commit National Reconstruction Fund (NRF) investment to re-shoring food manufacturing.
• For food infrastructure projects to be fasttracked through special investment designations, and for
• Both sides to pledge bipartisan support for Australian agriculture.
“It’s all very well to ask consumers to buy Australian, but when the government is only paying lip service to supporting our farmers and retailers are chasing the lowest prices around the world, individual action is not going to get us anywhere,” Mr Dorber said.
“The Government must restore food sovereignty to this country and fix the crisis that is seeing farming industries dwindling or disappearing altogether and they must act now or it will be too late.”
Mr Dorber called into question the seriousness of Labor’s $3.5 million ‘Feeding Australia’ pledge.
“Three and a half million dollars to create a ‘plan’ does not sound like actual support for farmers to me,” he said.
“Let’s do the maths: three million tonnes of fruit and veggies go to waste every year and the average price of veggies today is around $5/kg –fruit is more.
“So very conservatively, in the next two hours, $3.47 million worth of fresh Australian produce will be wasted due to policy failures.
“The government is pledging two hours’ worth of fruit and veggie waste to fix our national food supply? I don’t think so.”
Mr Dorber also called on the Government to ensure the NRF was supporting critical food supplies and to create a special “essential development“ designation for food infrastructure projects, providing not just financial investment, but also tax incentives to drive more private investment and fast-track infrastructure builds.
“This is exactly what the NRF should be for,” he said. “Beetroot is a prime example – last year we had a canned beetroot shortage because we’re so reliant on imports and why? Because there’s nowhere to can beetroot where the stuff is actually grown,” he said.
“All our fruit and vegetable processing plants are decades old and owned by US, Canadian and other overseas interests – and if you can’t see why that’s a problem then you shouldn’t be making agricultural policy.”
Mr Dorber said the current geopolitical climate had forced the problems of globalisation to centre stage – and nowhere were these more pressing than in our food supply.
“Did you know that up to 88 per cent of any given crop we grow may be left to rot in the field, because the produce doesn’t fit ‘perfection’ stan-

dards for supermarkets?” he said.
“And, because there’s nowhere to have those crops processed into frozen, canned or other products, the farmer loses 88pc of their income and Australians lose 88pc of the fresh, homegrown food they could have enjoyed.
“It’s an absolute disgrace but the good news is, there are plenty of people like us ready to fix this.”
According to Freshlogic, fresh vegetable prices were up almost 25pc at the end of 2024. With one in three fruit and vegetable farmers considering leaving the industry due to economic pressures, these issues are only likely to worsen without decisive intervention.
“The movement must start now – a powerful bipartisan movement to reclaim ownership of Australia’s food supply for Australians,” Mr Dorber said.
“That means bringing manufacturing back; bringing support for farmers back, and growing and processing the food we need right here in Australia.
“If that’s not a matter of national pride, I don’t know what is.”

AgForce is calling for boldness and inclusivity from all political parties in their election commitments around nature.
Not more posturing, empty undertakings and exclusion from the development of new policy settings as we have seen in abundance from all sides this term.
A great example of this is how in the dying moments of the 47th parliament, the Environment Protection and Biodiversity Conservation (Reconsiderations) Bill 2025 was snuck through.
It is difficult not to roll the eyes at the obvious political expediency shown by the passing of that legislation, especially in the context of the pending election, as the issue had long been in front of the Environment Minister for consideration.
MICHAEL GUERIN
In short, the bill limits the ability of the En vironment Minister to go back and reconsider a past approval - if the conditions of the approval are being met - not a bad thing if you want in vestment confidence!

But what’s more galling for industry and regional communities is that the desperately needed broad-based reform of ‘Nature Positive’ laws has been sidelined yet again without reso-
lution by another term of parliament.
Instead of bringing in the courageous policy settings so critical for the future of our industry, all we saw was a small politically convenient last-minute manoeuvre and not so much as a whimper from elsewhere in the chamber.
The opportunity for Australia and all Australians is vast if we collectively embrace this challenge, but the necessary reform of the Act is way overdue to enable that to be realised across environmental, social and economic elements.
Just in February of this year, ABARE released the first ever Australian ‘National Ecosystem Accounts’ - showing a $43b opportunity.
The appraisal was a financial assessment of our ecosystems – including deserts, grasslands, native forests, rivers, streams, coastal areas and
oceans ...
Industry, Regional and Rural Australia and the wider community need to work together as equals in the co-design work of this critical reform process.
This was sadly absent in attempts at the reform process in this past term of the federal government.
The fact is - our agricultural industry has much to contribute to the conversation and reform agenda.
Let’s keep the pressure on all parties on this issue all the way to 3 May 3 and then grab the opportunity we know is there with both hands.
Further strengthening food security and building resilient landscapes go hand in hand –what an opportunity we have to highlight to all Australians how crucial we are to that equation.
By Breanna Lloyd
An election commitment has been made to fund an essential upgrade to one of the state’s largest livestock exchanges, CQLX Gracemere Saleyards, under a future Coalition Government.
Leader of The Nationals, David Littleproud, and Federal Member for Capricornia, Michelle Landry, announced on Wednesday, 2 April, that the saleyards will receive $5 million if the Coalition is re-elected.
The upgrades will include a 12,500-squaremetre rooftop over the cattle yards and a rainwater capture system.
“Our cattle industry is going through a particularly tough time right now and deserves support,” Mr Littleproud said.
“It’s important to continue investing in these saleyards and give producers confidence that they have the appropriate facilities to use.
“The CQLX is one of Australia’s most important saleyard facilities. I am proud to back this announcement to ensure our industry gets the crucial support it needs, especially during this difficult period out west.”
The refurbishment will support hundreds of cattle farmers, with 120,000 cattle sold annually at the exchange.
Ms Landry said construction would begin as soon as possible under a future Coalition Government.
“Central Queensland is known for selling not just Australia’s, but the world’s best beef,” Ms Landry said.
“The CQLX is also regarded as one of the best stud-selling facilities in the country, and this is an extremely exciting announcement for the region.”
Regional Livestock Exchange (RLX) has been working closely with Rockhampton Regional Council to bring this important project to fruition for the community.
Since 2010, the council has invested over $14 million into the facility.

RLX chief executive officer Brett Freer said the funding would support upgrades that had been years in the making.
“We welcome the Coalition’s pledge to the facility and the investment in advancing our sector, providing improved animal welfare conditions, enhanced water and environmental management, and an improved experience for the many industry and community users,” Mr Freer said.


“We have a long history of investing in CQLX and ensuring Rockhampton remains the Beef Capital of Australia.
“The facility holds a prestigious place in our industry, and we see this investment as securing a bright future for the stud, commercial, and logistics sectors.”
“Being in the Beef Capital of Australia, this really cements Rockhampton’s position in the industry,” he said.
“We understand the welfare of the animals is crucial, so upgrading these facilities will be the best outcome for the local economy and jobs, ultimately benefiting our community as a whole.”
Rockhampton Regional Council Mayor Tony Williams echoed Mr Freer’s sentiments, saying the announcement was fantastic for the beef industry.









Microbial biotechnology that has been demonstrated through field trials at the University of Queensland (UQ) could be a game-changer for farming with simultaneous benefits for soil regeneration, crop yield and carbon sequestration.
UQ’s Queensland Alliance for Agriculture and Food Innovation and the School of Agriculture and Food Sustainability have collaborated with agri-biotech company Loam Bio to test fungal endophyte inoculants in soybean plants.



Dr Vijaya Singh, a research Fellow at QAAFI, said fungal endophyte inoculants were beneficial microbes that were put on seeds to make it easier for plant tissues to be colonised.
“It’s a symbiotic relationship – in return for providing the host plant with nutrients and water the fungal microbes get carbon as a food,” Dr Singh said.
“Atmospheric carbon fixed by the plant flows into the soil via fluids released by the roots, increasing the soil carbon rather than removing it.
“More carbon means more grain yield, which is why it’s exciting for me because we’re doing meaningful research.
“Building carbon in the soil improves the soil structure, increases the water content of the soil and nutrient availability and capture.”
Loam Bio has been developing the inoculants for more than four years.
Company researcher Dr Neeraj Purushotham said the results in the first year of trials at Gatton in Queensland were encouraging.
“What we are looking at with our UQ collaboration is to understand more deeply how our inoculant works and also understand how stable carbon is built because that is what stays in the soil,” Dr Purushotham said.




































If you can’t vote on Saturday 3 May, you may be eligible to vote early.
All Australian citizens aged 18 years and over are required by law to vote.
So, if you can’t make it to a polling place on election day, you may be eligible to: · vote early at an early voting centre, or · apply for a postal vote.
If you’re travelling, working or will be outside the electorate where you’re enrolled on election day, you can vote early.
To check early voting options and eligibility, visit aec.gov.au/early
Your vote will help shape Australia.
To learn more aec.gov.au/early 13 23 26
“By increasing the amount of carbon sequestered you’re helping the farmer because the healthier the soil, the less fertiliser you need.
“That would mean reducing the use of fertilisers while generating the same benefit in terms of yield, as well as getting carbon inside the soil.”
Dr Singh said the results warranted further investigation.
“Our findings suggest the endophytes have potentially beneficial impacts on crop growth, yield and play a role in altering soil organic matter,” he said.


Queensland is currently grappling with severe flooding, with record-breaking rainfall inundating large parts of the state.
Major flood warnings have been issued for multiple rivers, including the Thomson, Barcoo, Bulloo, Paroo and Warrego, as water levels continue to rise.
Vast areas of western and central Queensland have been submerged, with floodwaters surpassing levels seen during previous major flood events.
The devastating impact on agriculture has been immense, with a significant number of livestock lost and much of the farmland destroyed.
Stock losses are expected to reach into the hundreds of thousands, compounding the already difficult conditions caused by ongoing droughts.
This disaster has left farmers across these affected regions in urgent need of support to recover from the extensive damage and ensure the survival of their remaining livestock.
Rural Aid has swiftly mobilised to deliver critical relief to affected farmers. In collaboration with the Queensland Government, Rural Aid is ensuring that resources and aid are being directed to the most impacted areas.
A key initiative has been the airlifting of bales of hay by helicopter to farmers who have been cut off by the floods. These airlifts provide essential sustenance for stranded livestock, which is a lifeline for farmers unable to transport feed due to the devastating conditions.
Beyond immediate food relief for livestock, Rural Aid is also addressing the financial strain on farmers. Farmers from across the state have already been issued prepaid Visa cards, providing them with direct financial assistance to help them cope with the economic challenges they are facing.
Rural Aid CEO John Warlters, who is currently in Charleville coordinating relief efforts, said:

“The flooding in Queensland has created an incredibly challenging situation for farmers.
“We’re doing everything we can to provide immediate support and ensure farmers have the resources they need to care for their livestock.
“The scale of this disaster is overwhelming, but with the ongoing generosity of the public, we can make a real difference for those impacted.
“I’ve seen first hand the strength and resilience of the farmers here, but the road to recovery will be long. Rural Aid is committed to supporting these communities every step of the way.”
Rural Aid’s support extends to long-term recovery, with a variety of ongoing initiatives aimed at helping farmers rebuild and recover.
The public can contribute to these efforts by


donating through the Rural Aid website at www. ruralaid.org.au/donate.
Donations will play a crucial role in providing ongoing support to farmers, helping them recover and rebuild in the wake of this disaster.
Affected farmers can also register for assistance at www.ruralaid.org.au/services-provided/ or can call 1300 327 624.





By Warwick Lorenz*
It’s Cyclone season up in northern Queensland and it played havoc with the tourist business and didn’t help the sugar cane industry one bit! Not only that but, enormous amounts of silt-laden water were dumped on the Barrier Reef!
The damage and the cleanup bill from Tropical Cyclone Alfred in 2025 was devastating and it’s astonishing the way North Queenslanders can deal with challenges like that.
Australian Pump Industries is particularly sensitive about the water issues facing Australia now and in the future. We are told by politicians that there is a housing shortage, that real estate prices in the capital cities are beyond the means of ordinary citizens and yet, we’re reminded that this is an island continent of almost 3,000,000 square miles. How can we be short of living space?
We all know that the economy is built around mining and agriculture. These industries depend on one critical resource - water. Despite its importance, Australia’s water security remains a persistent challenge with either too much or too little, and often when we don’t want it.
The team at Australian Pump and their dealers around the country are more than conscious of this, just as every farmer and mining company is. We see massive floods that cause heartache, sometimes horrific stock losses, flatten sugar cane and denude paddocks of essential topsoil.
A MISSED OPPORTUNITY
The great Australian Artesian Basin, one of the largest underground water reservoirs in the world, spans nearly a third of the continent. This immense resource is replenished by monsoonal rain and has the potential to transform regional Australia. Coastal rivers like the Fitzroy, the Ross, and the Burdekin regularly flood, taking valuable topsoil.
Allowing that water to be wasted and worse, to possibly deliver crippling blows to the Barrier Reef, is the result of a lack of strategic infrastructure projects.
The Aussie Pumps team point out that since the Snowy Mountain Scheme, developed under the stewardship of Robert Menzies, Australia has seen little progress in building the systems needed to ensure water security.
Visionaries like John Bradfield, renowned for designing the Sydney Harbour bridge, recognized the potential of Australia’s water resources. In 1933, Bradfield proposed redirecting northern rivers into the Murray Darling basin to irrigate drought-stricken regions and support agricultural productivity, and yet, almost a century later his vision remains unrealized.
Farmers, miners, and regional communities are left asking why have our leaders not moved?
LESSONS FROM THE PAST
In 1946, the Australian military forces - 1,000,000 men and women in uniform (1/7 of the entire population of Australia) - were demobilised. The nation breathed a huge sigh of relief that the war was over, and we could go back to the peaceful development of the country.

A journalist, Luscombe, writing under the name of Veritas, identified water security as Australia’s most pressing issue. His detailed proposals for redirecting rivers to replenish the Great Artesian Basin by channelling water from the coastal rivers inland, remain just as relevant today.
Regrettably, political short-termism has hindered progress.
Ideas like the 100 Dams Program, developed by Tony Abbott and Barnaby Joyce, offered cost effective solutions. However, political instability derailed their implementation. Real progress requires long term commitment. That may only be achievable by extending Federal Government terms to enable large scale planning. Why not utilise a five-year term like the UK, or at least a fouryear term like the USA?
Australia’s farmers are among the best, in the world. The agricultural production that this small number of our citizens produce is a great credit to their effort, ingenuity, and of course courage. Who hasn’t lived through a drought, and wished there was adequate water storage to enable the farming and mining activities to continue uninterrupted.
Crops and livestock will become progressively
more important as the world’s population continues to rise. We’re told by the United Nations that global population will rise to an estimated 12.5 billion souls by the year 2050. Australia has a critical role to play in feeding the world! Current agricultural output will need to double, perhaps even triple, to meet this demand.
At Aussie Pumps, working with the construction industry, farmers, and miners, we know that flood mitigation and water preservation is just a matter of cost and more importantly, will!
We’ve developed heavy-duty, 6000 litre per minute, 6-inch, self-priming pumps that are proving themselves outside of Australia. The big
Aussie MQ600TD is powered by an 80 hp Deutz, air-cooled diesel engine, and comes on a heavyduty skid with an integrated fuel tank that enables it to run for 11 hours straight.
These mighty pumps, used by Australia’s mining giants and earthmoving contractors, and more recently by local government bodies, are currently in use in South Sudan. Aussie Pumps has up to 25 of these big beasts now operating under the auspices of the United Nations, prepping for the next flood to hit the capital city of South
In the last floods hitting Juba during the monsoon flood season, these pumps moved 8 million litres of water per hour, diverting the Nile River and saving Juba from catastrophic floods.
Aussie Pumps builds those pumps and even now are processing orders from local government bodies in Australia who don’t have the funds to invest in huge concrete flood mitigation infrastructure. Our trailer-mounted pumps can be deployed where required easily, with great results!
Australian Pump, a 30-year-old Australian start-up, depends on a wide network of highly ethical and professional distributors to market their high-quality products. The company produces what are claimed to be the best lightweight portable fire pumps in the world. They export them to Europe, Indonesia, and more recently, New Zealand.
* The above story was written by Warwick Lorenz, Managing Director of Australian Pump Industries. Warwick is a passionate advocate for bringing water security to regional Australia. To connect with Warwick, email wlorenz@aussiepumps.com.au.
















The 2025 Neogen World Angus Forum, a leading event in the Angus beef industry, has announced its upcoming world forum in Brisbane from 7 to 8 May 2025 will be centre stage for the global beef industry.
This event is set to bring together breeders, researchers and industry leaders from more than 26 countries, offering an unparalleled opportunity to explore advancements in the Angus cattle industry.
“There’s just no way this is harming the planet,” said World Angus Forum committee chair Erica Halliday.
“The natural, biogenic carbon cycle of drawing down carbon into plants, then cattle eating those plants, converting it to protein then releasing the carbon back into the atmosphere is the way nature intended and she’s been doing it for millennia.”
Erica’s family property is located in the eastern New England district of NSW and she believes the way to move forward is education. “Understanding just how food is produced and understanding how we, as farmers, can access the tools to do it better is so important for the future.”
The forum will feature the Zoetis AngusEXPO, the largest registered Angus cattle exhibition ever held in Australia.
This includes the Cattle Breeders College, Cattle Chats, AngusCAMPDRAFT and premium events such as the Angus-BBQ competition, TEYS Australia AngusSHOOT-OUT awards dinner and Elite Female Sales.
With a diverse array of events, the forum aims to provide a well-rounded experience for attendees.
“Recently, Angus Australia joined with both the US and Canadian counterparts to compare genetic data across the countries, so we are engaging in a kind of diplomacy that goes beyond politics,” Erica said.
“The youth competition, for example, has international teams vying against each other in an almost Olympics-style format.
“Having those 18 to 25-year-olds engaging with each other from all cultures brings an understanding of each country far beyond the news or social media.”
The forum, which occurs every four years, was last held in Australia in 1997.
Discussions from that event forecast important industry trends and, this year’s theme, “Beef for a Better Planet,” aims to address sustainability from a holistic perspective.
Topics will include strategic planning, building resilience and mental health, as well as beefspecific subjects like genomics.
“This theme really addresses how beef can provide solutions to critical issues such as food scarcity and nutrition depletion while keeping farmers in business and being part of the solution to climate change,” Erica said.
Attendees are expected from 26 countries and the current tariff and trade war discussions are likely to arise during social events.
“This year’s forum sees a team of young people attending from Indonesia for the first time and we hope this paves the way for greater knowledge sharing with our closest neighbours,” Erica said.
The 2025 Neogen World Angus Forum
The 2025 Neogen World Angus Forum is the premier global event for the Angus beef industry, bringing together breeders, researchers and industry leaders from more than 26 countries.
As part of this landmark event, the Zoetis AngusEXPO will be the largest registered Angus cattle exhibition ever held in Australia, providing breeders with an unprecedented opportunity to showcase their genetics on the world stage.
The EXPO will feature Cattle Breeders College, Cattle Chats, AngusCAMPDRAFT, the AngusBBQ competition, live music, the Teys Australia AngusSHOOT-OUT awards dinner, Angus on Ice Genetics Sale and Elite Female Sales.
It is an unmissable event for the global beef industry.





Country music is set to become the soundtrack of the famed Scenic Rim Clydesdale Spectacular this year.
Organisers have announced a major new addition to the two-day celebration - A Country Concert starring much-loved Queensland country performer Luke Geiger to be held on Friday 13 June.
The Scenic Rim Clydesdale Spectacular is the richest Clydesdale Show in the Southern Hemisphere and will be held at the Beaudesert Showgrounds on 14 and 15 June, with the Country Concert on Friday evening, from 5pm.
The event marks a special homecoming for Luke, who played rugby league in Beaudesert in 1995 at the state trial, where he was selected for an NRL scholarship.
Now, almost three decades later, he returns to
Beaudesert not on the footy field, but on stage, ready to deliver an electrifying live performance.
“I’m a country singer and a horse guy and I can’t wait to get around the big horses at the Clydesdale Spectacular — what an experience it’ll be!” Luke said.
Known for his high-energy, powerhouse performances, Luke Geiger has become one of the most sought-after country performers in Queensland.
Drawing inspiration from country music legends such as George Strait and Garth Brooks, Luke’s dynamic sound and electrifying stage presence have captivated audiences across the state.
His passion for Cowboy Country Music and his authentic storytelling continue to cement his reputation on the Australian country music scene. Adding an extra local connection to the per-

The prize pool on offer at the Royal Queensland Show’s (Ekka) country music talent search keeps getting bigger, with the Ekka’s Country Music Showdown delivering a greater cash prize and more paid gigs to the winners of this year’s competition.
Entries are now open for the 2025 competition, which gives rising country music stars the chance to be discovered and to win a share of the massive prize pool, valued at more than $70,000 this year.
The 2025 Country Music Showdown’s overall cash prize has increased to $3000 and the Open Category winner will enjoy more paid performances than ever before with this year’s introduction of a gig at the hugely popular Lefty’s Music Hall in Brisbane, in addition to appearances at the Gympie Music Muster and Ekka 2026.
Musicians aged 12 years and over will compete in the ultimate talent search, with finalists performing two songs to Ekka crowds and a panel of industry judges, on stage at the XXXX Stockmen’s Bar and Grill on Saturday 16 August.
There are two categories in the Showdown:
Junior (ages 12-17 years) and Open (18-plus years) and the 2025 cash and prize pool includes the Troy Cassar-Daley Scholarship to the Academy of Country Music in Tamworth, music video and website production services, a photo shoot package, musical equipment and interviews and airplay on Kix FM.
Head of Ekka Entertainment and Education Tony Laffan said the Ekka was proud to be unearthing the next generation of country artists.
“We were delighted to see that the previous winner of both the Ekka Country Music Showdown’s Junior and Open categories Felicity Kircher was recently named the 45th Star Maker at the 2025 Tamworth Country Music Festival – Australia’s most prestigious country music competition,” he said.
“Ekka is all about celebrating the best of Queensland and we’ve seen many talented artists emerge and start their careers off the back of this wonderful competition.”
Thinkyou’vegotwhatittakes?Thensubmit yourvideoapplicationsnowatwww.ekka.com. au/entertainment-program/entertainment/ country-music-showdown/#iwanttoenter
formance, Luke’s steel guitar player is based in Tamborine, bringing the spirit of the Scenic Rim straight to the stage.
The Scenic Rim Clydesdale Spectacular celebrates the heritage and history of the Clydesdale horse, an animal synonymous with Australia’s pioneering past.
From competitions showcasing the power and grace of these magnificent horses to an array of family-friendly activities, demonstrations and now a country music concert under the stars, this year’s event promises to be …. Spectacular!
The Scenic Rim Clydesdale Spectacular will be staged in the middle of the famous SCENIC RIM EAT LOCAL MONTH, creating just another reason to visit, stay and experience.
The region has a long history and connection with the Clydesdale.
“OurregionowesmuchtothemajesticClydesdales, which played a key role in establishing the Scenic Rim’s incredible agricultural base by clearing vast tracts of land, ploughing the paddocks and bringing in the harvest,“ Greta Stanfield said.
“While the advent of machinery saw a decline in the breed in the 1960s, the efforts of breeders and this event committee to preserve and celebrate the 130-year history of these gentle giants here has resulted in the Scenic Rim Clydesdale Spectacular becoming one of Queensland’s most significant events.“
* To win three family passes (four tickets each) to the Luke Geiger Concert on Friday, 13 June and three family passes (four tickets each) to the Scenic Rim Clydesdale Spectacular the next day please contact Kath Rose at kath@kathrose.com.














By Maddison Richards
Briar Steinhardt is a young woman who has country blood in her veins, which has brought her numerous opportunities.
She is a Year 12 student and the 2025 school captain at St John’s Lutheran School Kingaroy, in the South Burnett, and was one of the 38 winners Australia-wide of the Heywire competition.
The Heywire competition challenged participants like Briar to submit a true story about their life. Briar talked about how moving to the farm changed her life.
“I could never live back in town,” Briar said. “It just felt surreal,” she said when asked how it felt to be a winner. “I remember jumping up and down, I was so excited.”
“I probably didn’t realise how big the program was.”
In early February, Briar alongside the other Heywire winners, travelled down to Canberra for five days, where they had the opportunity of a lifetime to talk to politicians about how to improve rural areas.
“You know, all these rural kids coming to one spot, especially in a city where no one’s really gone to, it was pretty cool,” she said.
At Parliament House, the winners talked to the politicians about what rural kids needed and started to create programs on the results of that discussion that would seek funding.
“It was good to talk to other kids that were similar to me and wanted to improve rural communities,” Briar said. “It was amazing how well we clicked.”
“It was awesome to get to know people and meet new people from across Australia,” she said. “I now have friends in Tasmania and in Western Australia. It’s just so cool.”
Briar had not previously met any of the other winners, but clicked so well with her flying buddy, a girl she was seated next to on the flight from Brisbane airport to Canberra, talking together as if they were old friends catching up.
As part of the prize for being one of the Heywire winners, Briar met up with some of the politicians down in Canberra.
“It was definitely a change of scenery compared to talking to people out here,” she said. “It was cool though, but some of them tried to relate stories back to small communities but didn’t quite get there.”
Briar said it felt like one of the first times she felt seen as an adult, which was pretty cool.
The curiosity mounts as we ponder what Briar wrote about with such passion that she was announced as a winner.
The answer is simple. She spoke about her

own life’s journey about how, in Year 5, she moved to the farm she now calls home.
“I’m not a farm born kid,” Briar said. “I wasn’t raised there.”
She spoke about how the move changed her, helped her come out of her shell and built her confidence.
“You get to be as loud as you want out on the farm,” she said. “It just brought a whole different side I didn’t think was possible.”
She finds great comfort in the tight knit community that Wooroolin is, and finds that it’s close enough to town that it’s not too long a bus trip to school, but far enough away you get to live your own life.
“It’s quite fun, just running through the paddocks and whatnot,” she said.
Her father was born a farm kid, and had a strong desire to return to the fenced pastures, however, her mother had no desire to live in an old farm house, so after ten years of searching, beginning before Briar was even born, they found
the perfect place.
“Once they found the one, we were pretty much moving in,” Briar said. “It was cool.”
Moving from town with many family members living on the same street, to the perfect farm getaway allowed Briar to grow to be the young woman she is becoming.
Briar became aware of the Heywire competition when one of the teachers at St John’s made an announcement at assembly, and after realising she fit the criteria, she decided to enter, assuming there would be numerous people, but found she was the only one.
What she found really interesting was that you could submit as many entries as you desired, so she submitted two, doubling her chances of being selected as a winner.
With the help of a producer that she met prior to the competition, Briar had the honour of being selected.
“I had no idea and I guess it’s just one of those things where the opportunity presented itself and
you kind of just take it,” Briar said.
Briar attended St John’s for all her schooling life, from Kindy to Year 12, where she is now school captain for the second time.
She was school captain back in Year 9, when the school was extending to accommodate up to Year 12. Briar and her family jumped aboard this decision.
“I could have done good at any other school, but this is home,” she said.
“I decided to be school captain just because of all the opportunities it gave me,” Briar said. “I get to have a voice, especially for all the students at school that don’t necessarily get heard the first time.”
“It’s cool to have the responsibility of the role. It builds confidence and kids can look up to you and approach you, which is pretty cool.”
“A second year in the role is definitely better,” she said. “You definitely start pinpointing what’s more important and what’s not.”
Briar wanted to be the face of the school and step out and meet new people.
As school captain, Briar has one goal.
“To be the role model students want to see and teachers want to have a chat with,” she said.
As school captain, Briar loves the environment it provides, allowing her to have adult conversations with the school’s staff, and allows her to see all the doors the position provides.
Briar’s dream career would be to work in the agribusiness, though she’s still unsure whether that would involve working for a company or starting her own.
One thing she does know is that the Heywire competition provided her a stepping stone.
The CEO of Agrifutures Australia approached her and offered her a scholarship to study with them for her second year of university, after assuming Briar was in her first year of university, not a Year 12 student.
“I’m unsure where that opportunity will take me, but I have reached out to them, and am waiting for a response on that.”
Briar would like to share some parting words of advice.
“If there’s any kids looking into the Heywire program or even any other opportunity, just take it, because the worse they can say is no.”
The Heywire competition is open to young peopled aged between 16 to 22 years of age in regional, rural and remote Australia.
Entries close on 1 September 2025, and must be a true story about an aspect of the entrant’s life. To enter visit: abc.net.au/heywire/competition
By Fiona Gowers
Women in regional communities will soon be able to access support from a life coach through online consultations and in-person workshops.
Carlen Lesley will expand her coaching practice in response to growing demand for personal development services in rural towns.
She will host sessions through online video platforms such as Google Meet and launch monthly online workshops for regional women to connect and support each other as they work towards important goals.
“I want country women to know that support is available if they’re feeling stuck or need guidance with a specific situation or goal,“ Ms Lesley said.
“My service is specifically for women who may not need the help of a psychologist but would like someone to cheer them on, challenge what is holding them back and get them moving towards what is meaningful to them.
“As someone with deep regional roots myself — born in Boonah, having lived in Toowoomba and grown up on the Sunshine Coast — I understand the unique challenges regional communities face.“
According to Ms Lesley, many women in
their midlife years find themselves at a crossroads, particularly in regional areas where support services can be limited.
They have dedicated decades to their families, careers or both and are now ready to rediscover themselves and write their next chapter.
The coaching program specifically addresses the unique challenges faced by women in regional Australia, including:
• Navigating significant life transitions such as empty nesting or career changes, and
• Rebuilding identity and confidence after years focused on others.
Women across regional Australia can now access these transformative coaching services through secure video consultations, eliminating the barrier of distance.
“Geographic location shouldn’t limit anyone’s access to personal development resources,“ Ms Lesley said.
“Every woman deserves the opportunity to explore her potential and create a fulfilling life, regardless of where she lives.“
The program includes:
• One-on-one coaching sessions tailored to individual needs
• Monthly group workshops and discussions
• Access to digital resources and exercises
• Flexible scheduling to accommodate various time zones.
To celebrate this expansion, Ms Lesley is offering free 30-minute “discovery calls“ to women keen to learn more about how identity and purpose coaching can support their journey.
For more information or to schedule a discovery call, please visit: www.carlenjcoaching.com
About Carlen:
Drawing from her extensive healthcare background and deep commitment to social justice, Carlen specialises in guiding women through midlife’s most profound transitions.
Her coaching practice offers trauma-informed support to women in regional areas who are navigating significant life changes.
Having walked the path herself through empty nesting, relationship transitions, career evolution and health challenges, Carlen brings both professional expertise and lived experience to her coaching practice.
She understands first-hand the complex emotions and adjustments that come with these pivotal life moments.

communities face. (Supplied)
By Fiona Gowers
The 2025 Queensland AgriFutures Rural Women’s Award winner is Nicole McNaughton.
Nicole, CEO of the Food and Agribusiness Network (FAN), was recognised for her efforts to strengthen regional food and agribusiness industries.
She heads one of Australia’s leading food industry clusters, connecting and supporting more than 420 members from the Moreton Bay, Sunshine Coast and Gympie regions to foster collaboration, growth and innovation.
A passionate advocate for regional agribusiness, Ms McNaughton has dedicated her career to connecting producers, manufacturers and industry leaders, ensuring regional food businesses can thrive in domestic and global markets.
“The success of regional agribusiness depends on strong collaboration and FAN exists to bring people together producers, innovators and businesses to grow stronger as a collective,” Ms McNaughton said.
“This award is a testament to the impact of our food and agribusiness community in Queensland and I’m honoured to champion the incredible work being done across our regions.”
Ms McNaughton will use the $15,000 Westpac grant to further develop FANs and participate in a professional development course.
She will also represent Queensland at the AgriFutures Rural Women’s Award gala dinner and national announcement in Canberra later this year, where the winner will receive $20,000 and the runner-up $15,000.
Minister for Primary Industries Tony Perrett congratulated Ms McNaughton and praised her commitment.
“Nicole is playing a pivotal role in advancing Queensland’s food and agribusiness sector, creating opportunities for producers and businesses to scale, innovate and succeed.
“Her leadership through FAN is helping to strengthen Queensland’s $23 billion agricultural


industry and this award recognises the impact of her vision and dedication.”
AgriFutures Australia managing director John Harvey emphasised the significance of the Rural Women’s Award in supporting projects that drive innovation, strengthen industries and create lasting benefits for rural and regional communities.
“The AgriFutures Rural Women’s Award celebrates leaders who are shaping the future of regional Australia and Nicole McNaughton’s work
exemplifies the power of connection and collaboration in driving industry success.
“By supporting agribusinesses to grow and innovate, Nicole is not just strengthening Queensland’s food industry, she’s ensuring its resilience for generations to come.”
Simon Thurbin, regional general manager southern QLD, Regional and Agribusiness for Westpac, underscored the importance of the AgriFutures Rural Women’s Award in recognising


the contributions of women in Australia’s food and agribusiness sector.
“Westpac is proud to support the AgriFutures Rural Women’s Award, which highlights the critical role women play in shaping Australia’s rural and regional industries.
“Nicole McNaughton’s work with FAN demonstrates the strength of community-led collaboration and we are excited to see the continued impact of her leadership.”

By Fiona Gowers
Mums in the Isaac region are invited to celebrate Mother’s Day and raise funds for Motherland, a national charity that supports rural women’s mental health.
Motherland’s goal is to ease rural mothers’ crippling isolation by connecting them to a supportive online community and facilitating a virtual mothers’ group program.
Buy From The Bush founder Grace Brennan is the guest speaker at the event, which takes place at the Clermont Showgrounds Pavilion on Friday, 6 June at 11am.
The event will raise vital funds for Mother-
land, allowing it to continue to expand its impact.
Since its launch in 2019, Motherland has helped thousands of Australian women through its Motherland Connect platform, Motherland podcast, Motherland Village program, Scholarship fund, events and advocacy.
“(I am) overwhelmed with gratitude to be able to host this event in Clermont,“ said Motherland Clermont event ambassador Rhiannon Finger, who will host the event in June.
She said she hoped the event would give the community as a whole a chance to unite for an afternoon of conversation and connection and learn more about Motherland’s support for ru-
ral mums.
Motherland founder and 2024 Australian of the Year for Tasmania Stephanie Trethewey said the charity had a proven track record of helping counter the physical and mental isolation of mothers living in rural areas across the country.
“Rural mothers are the foundation of rural and regional communities like Clermont,“ she said.
“They wear so many different hats and are the glue holding their homes together, but they’re often so busy looking after everyone else but themselves.
“That’s why we want to ensure every mother
who calls rural Queensland home has access to the critical support they might need throughout their motherhood journey.
“We are also thrilled to now expand our services throughout Queensland as a result of the Queensland Government’s three-year investment and we appreciate their support.
“Around 15 per cent of our charity’s engagement nationally stems from Queensland rural mothers and, with the state being such a critical part of our nation’s agricultural sector, we want to grow our impact even further to ensure no rural mum is left behind.”
* Please visit motherlandaustralia.com.au.



By Jane Lowe
Australia produces more than 50 per cent of world goat meat exports and the numbers of Boer goats in Australia continues to rise as farmers and graziers turn to goat meat production as a profitable alternative enterprise.
For the international and local producer, the Australian Boer goat offers a source of top quality genetics.
They are animals that have been selected to thrive in a range of farming conditions.
It is a highly versatile breed that complements other livestock production and a cost effective meat production resource.
The product of a clean, pristine sea-locked continent, which is free from many diseases.
The Boer Goat originated in South Africa in the early 1900s where it was developed and bred by selection and sound breeding practises from native African goats.
The word Boer in Dutch means farm so the Boer Goat was originally known as the “farmers’ goat”.
Boer Goat genetics were imported into Australia via New Zealand in the late 1980s and early 1990s from several South African studs.
The first pedigreed Boer goats were released for breeding programs in Australia in 1994.
Angora goats bred for mohair fibre really did not take hold in Australia until the 1970s.
The goat prefers a scrub habitat and in Turkey, South Africa, Texas and Patagonia the Angora is largely relegated to semi-desert areas of low land value but with a considerable supply of labour from indigenous sources.
Angoras form a specific breed of goat which have been traced to the Anatolian plain of Turkey.
Unlike most breeds the Angora produces a full fleece of wool-like fibre referred to as Mohair.
Mohair varies in fibre diameter depending on age and size of the animal and so has a wide range of applications in textiles.
Kid mohair is the finest (20 to 28um) and is used in suiting and knitwear.
Mid range mohair referred to as Young Goat (28 to 32um) is used for hand knitting yarns and general apparels including coating and outer knitwear. Adult mohair (32um and up) is more appropriate for rugs, blankets and upholstery including velours or velvets


5 - 9M -350X350X12.5-$1200 *BLACKPOWDERCOATED
- 3M -75X75X3-GALV-$45
- 6M -100X50X3-PTD-$60 15 - 8M -125X75X5-PTD -$250 CATTLE-RAIL-GALV
•115X42X1.8-6.1M-$55LEN
•115X42X2.0-6.1M-$60LEN
•115X42X2.5-6.1M -$70LEN BUNDLES21LENSONLY CATTLEPANELSBUNDLEPRICE
•1.8MX2.1M-6RAIL
•40X40-GALVRHS •PINSINCLUDED 92-PACKBUYS-$85EA LOOSEBUYS-$100EA •SLIDEGATE-$400EA RHS-NEARNEW-PAINTED
•2.4M-LENGTHS $BUNDLE$BUNDLE 500- 40X40X2 -64/LENS -$400 1200-
PLATEHEAVY-2400X1200
1.6MM -$125 8MM-$600
2.0MM -$150 10MM-$760
3.0MM -$230 12MM-$900
4.0MM -$300 16MM-$1300
5.0MM -$380 20MM-$1600 6.0MM -$460 25MM-$200
U-BEAM-12M
•150UB14- $500 •200UB29 - $1000
•150UB18- $650 •250UB25 - $920
•180UB16- $570 •250UB31 - $1100
•180UB18- $650 •250UB37 - $1300
•180UB22- $800 •310UB32 - $1100
•200UB18- $650 •310UB40 - $1450
•200UB22- $800 •310UB46 - $1650 •200UB25- $920 •360UB44 - $1600
- $4575X75X8 - $200
50X50X5 - $70100X100X6-$220 50X50X6 - $85100X100X10-$340 FLATBAR-6M 20X5 -$1450X10 -$65
-$1265X5 -$40 25X5 -$1565X6 -$50 25X6 -$2065X8 -$65 32X6 -$2565X10 -$80
40X3 -$1875X5 -$70
40X5 -$2575X6 -$60
40X6 -$3075X8 -$80
40X8 -$4075X10 -$100
40X10 -$5075X12 -$120
50X3 -$25100X6 -$80
50X5 -$30100X8 -$100
50X6 -$40100X10 -$130
50X8 -$50100X12 -$150
GOATPANELS-BUNDLEPRICE
•1.2MX2.2M •8RAIL-GRADUATED
•2.5MMOD-GALVPIPE
•PINSINCLUDED PACKBUYS-93-$90EA LOOSEBUYS-$100EA
•GOATPANELGATE-$250 GATES-GALV
•10’-3M -MESH-$120
•12’-3.6M -MESH-$140
•14’-4.2M -MESH-$160
•10’-3M -5BARLIGHT-$140
•12’-3.6M -5BARLIGHT-$160
•14’-4.2M -5BARLIGHT-$190
•12’-3.6M -5BARHEAVY-$180
•14’-4.2M -5BARHEAVY-$210 BARBEDWIRE
•2.5MM-IOWA-400MROLLS
PALLETBUYS-27ROLLS-$125EA SINGLEROLLS-$135EA
•1.8MM-HIT-500MROLLS
PALLETBUYS-36ROLLS-$115EA SINGLEROLLS-$125EA
FENCEPOSTSPICKETS
•165CM-5’6”BLACK-HEAVY-$7.50
•180CM-6’BLACK-HEAVY-$8.50
•180CM-6’HDG-HEAVY-$9.00
CATTLECABLE
•8.2MM-7STRANDGALV
•400MX150KG -$550
HINGEDJOINT/FIELDFENCEFIXEDKNOT CATTLEGRIDHEAVY
•4MX2M-800KG-$2700
CONCRETEABUTMENTS
•4M-3000KG/PAIR-$1800
GALVGRIPMESHWALKWAY
•3000X600-$200
•3000X750-$220
RHS-2ND-GRADEEA/LEN
9-8M-125X125X4-GALV -$160
3-8M-100X100X6-PTD -$180
STRAINERPOSTS
•2.4M-80NBX4MM-GALV -$65
•3M-80NBX4MM-GALV -$75
•2.9M-80NBX5MM-PTD -$70
•3M-80NBX5MM-PTD -$75 BUNDLES19LENSONLY BLACKRUSTY
488-3100MM-40NBX3.2MM -$25/LEN BUNDLES-61-ONLY PIPE-NEAR-NEW $/LEN
329- 6.5M-15NB-MGPE -$15
237- 6.5M-20NB-MGPE -$18 STEEL PLATE - NEAR NEW
•2400 X 1200 X 1.6-$120
•3000 X 1500 X 2-$110
•3000 X 1500 X 3-$260
•3000 X 1500 X 6-$550
•3000 X 1500 X 25-$2000
GALV. PIPE MEDIUM
•65NB - 76MM OD X 3.6MM
HARROW-CHAIN-HEAVY
•6MX1.2M-800KGS $600ea
•SKILLION•GABLE •ZINCALUME•COLORBOND
FARMSHEDS-HEAVYDUTY STEELPLATE
•BISS80•BISS450 •ANYSIZE •ANYSHAPE •ANYTHICKNESS •ANYTIME
•3M - LENGTH $700 EA
•TROUGH - ENDS - 6MM $40 EA


•6.5M LEN/37 - BUNDLE $80 //LEN BUNDLES ONLY TROUGHS - 6MM STEEL 1M









By Jane Lowe
The Queensland Meat Sheep Young Judges state final was held at Toowoomba Royal Show.
Congratulations to Hannah Haupt who was named Champion and James Buchan who was awarded Reserve Champion.
Hannah will now compete in the 2026 National Final at Perth Royal Show.
Congratulations to all who competed.
What better way to celebrate the Australian Stud Sheep Breeders’ Centenary than three big days of stud sheep judging at the 2025 Toowoomba Royal Show?
Despite the weather, the stud sheep sectionin a new and improved location - was the place to be for 11 exhibitors with about 150 of the region’s best sheep on site.
The Australian Stud Sheep Breeders’ Association (ASSBA) came into existence in 1925 and in the past 100 years its members have achieved some incredible things in the Australian stud sheep industry.
As part of the centenary celebrations, a special supreme ASSBA exhibit was awarded to Suffolk ewe lamb bred and exhibited by Milton Park Suffolk stud.
All exhibitors also received a commemorative medallion for their attendance.




Results:
• Supreme Champion Ram - Sovereign Poll Dorsets.
• Supreme Champion Ewe, Morris & Noeleen Byrne Trophy - Eisentrager White Dorpers.
• Supreme Sheep of Show, Fred Bebbington Memorial Trophy - Eistentrager White Dorpers.
• Supreme Breeders’ Group - Malcolm Downs Suffolks.
• Lorna Jane Memorial Trophy, Champion Pen - Malcom Downs Suffolks.
• Champion Pair of Rams - Sovereign Poll Dorsets.
• Champion Pair of Ewes - Eisentrager White Dorpers.
• Champion ASSBA Ram - Calvary Christian College.
• Champion ASSBA ewe - Milton Park Suffolk Stud.
• Champion ASSBA Exhibit - Milton Park Suffolk Stud.
• Performance Class - 1. Sovereign Poll Dorsets, 2. Milton Park White Suffolk, 3. Malcom Downs Suffolks.
Samantha McConnell, Green Memorial Shield for Most Successful School, Scots PGC.

Celebrating 100 years of Sheep Breeding 1925 -2025 years of Sheep 1925 -2025
Congratulations to all those who exhibited at the ASSBA State Meat Sheep Show 2025 to all those who exhibited at the ASSBA State Meat Sheep Show 2025 in Toowoomba and our generous sponsors Ag Wholesalers, Westerham Concrete PBA in Westerham Concrete PBA Feeds, Elders, Queensland Electrical Solutions & ASSBA. Electrical Solutions & ASSBA.
Come and see our members at FarmFest Site LS42. All ASSBA studs are Brucellosis accredited. This advertisement proudly was sponsored by Malcolm Downs Su olk Stud, West Haldon, Sovereign Poll Dorset Stud, Warwick Milton and Hall Su olk and White Su olk Stud, Hendon, Calvary Christian College Su olk Stud, Carbrook.




By Jane Lowe
This is your chance to see Queensland alpacas, products, connect with potential producers and see what this amazing industry has to offer.
Two studs will open their farms in May, Double-H Alpacas at Yalangur near Goombundgee and Engle End Farm at Maleny.
An Alpaca Expo, to be held at Callide Valley Agricultural Show on 16 and 17 May.
Also, potential open farm at Samsuri Alpacas at Crows Nest.
You can also see Alpacas at the following events:
• May 16 and 17 Clermont Show.
• May 30 and 31 Maleny Show.
• May 30 and 31 Springsure Show.
• June 4 to 6 Knitfest at Maleny
• June 7, Yeppoon Show.
• June 11 and 12 Rockhampton Show.
• June 21 and 22 Mt Larcom Show.
• June 26 and 28 Ag-Grow Emerald.
• July 18 and 19 Gatton Show.
• August 9 to 17 The Ekka.
• August 23 and 24 Yarnfest at Redcliff.
Alpacas are now an established and beloved part of the Australian natural fibres, breeding and farming industries.
As the second largest alpaca industry in the world, following the Peruvian alpaca industry, Australia is at the forefront of breeding, fibre quality and development.
We have reached record prices and quality and
are moving from strength to strength, focused on increasing production volumes and improving consistency.
The Australian Alpaca Association plays a vital role in the current strength and continued development of the industry by providing education, communication, resources and marketing for the industry as a whole.
The international export demand for Australian quality alpaca fleece far outstrips demand, so the industry has great potential for further growth.
In support, the AAA encourages sustainable husbandry focusing on animal health, breeding programs and herd development.
Native to South America, alpacas have been in Australia for more than 35 years. Australia has one of the largest registered alpaca herds in the world, more than 160,000 animals.
Alpaca fibre is superfine and supersoft, prized for its soft, warm, light, fine and silky lustrous quality and are shorn once a year, yielding several kilos of precious fleece with every trim.
An efficient choice - alpaca produce quality fleece, lean and healthy meats and fine leathers with less environmental impact than many other livestock.
There are two breeds of alpaca – Suri (“SOOree”) have swathes of fine shimmering fleece that falls in locks from their bodies. Huacaya (“hwaKAI-ya”) grows volumes of fine, soft fleece in staples.
Both Suri and Huacaya are bred in a myriad of natural colours and multi-colours.





The Barn Oakey, Toowoomba’s go to for firearms and hunting gear, is pumped to join Farmfest, Queensland’s top farming expo. Based in Oakey, our family run business is showcasing cutting edge thermal optics, fireproof gun safes, and unbeatable ammo deals for farmers, hunters, and outdoor enthusiasts.
The barn this year are bringing a massive range of thermal scopes and monoculars to Farmfest, featuring the latest from Hikmicro, Nocpix, DNT, and Pulsar.
Standouts include the Hikmicro, Falcon and Lynx Pro with high-res imaging for all conditions and laser rangefinders Nocpix Ace H50R.
Game changing digital night vision scope such at the DNT Zulus scopes with HD displays and ballistic features.
Also on display is the Pulsar Helion 2 and Merger Duo are innovative multispectral binoculars combining thermal and digital night vision imaging in a single unit and offering enhanced detection, recognition and identification capabilities..
Stop by to test these top tier optics and find the perfect gear for nighttime hunting or surveillance.
Keep your firearms secure with Copperhead Armoury fireproof safes, available in 16- to 54gun capacities starting at $1099.
Built tough for fire and theft protection, they’re perfect for rural or urban use. Check them out at Farmfest for exclusive offers.
At Farmfest, we’re rolling out incredible ammo deals you won’t want to miss the Hornady Frontier .223: Just $975 per 1000 rounds, ideal for high volume shooters.
Top-quality Australian-made ammo ADI Ammo Cans will be available at unbeatable prices.
Stock up on these specials to keep your range sessions or hunts fully loaded.
Why Visit Us?
The Barn Oakey at Farmfest means hands on demos, expert advice, and exclusive deals.
The team are passionate about helping you pick the right gear, backed by their commitment to quality and community.
Swing by to explore the best in thermal optics, firearm storage, and ammo offers.
You will find them at D|13 at FarmFest 3-5 June 2025 or at 5-7 Campbell Street, Oakey, QLD, or online at www.thebarn.net.au.












Settled in an arid region just south of Roma, thirdgeneration grazier Sarah Packer is building her farming business on her family property “Hartwood“.
Divided by the Muckadilla Creek, the property boasts a diverse composition of black soil, red dirt, buffel grass and mulga trees, making it the ideal landscape for raising cattle, sheep and goats.
“Hartwood’s a pretty diverse block,“ Sarah said.
“We’ve got the Muckadilla Creek running through the guts of us, so you’ve got a little bit of that better black soil country and then you’ve got your red country with plenty of buffel growth through it, but we’ve also got the benefits of some red mulga country.
“It’s pretty drought resilient in a way that we can adapt when the seasons change.
“With all the different country types, I manage to run breeders, the cattle, I also run sheep for a bit of cash flow and goats because we’ve got plenty of regrowth around here.”
Keen to pursue a career in farming from a young age, Sarah’s parents supported her ambitions and provided plenty of opportunity for her to be involved in the family farming operation.
“I’m fortunate to come from a good family focused on giving the next generation a lot of opportunities.
“When I was keen and showed that I could handle a bit of responsibility and commitment, Mum and Dad were happy to give me a chance.“
Sarah originally heard about the Queensland Rural and Industry Development Authority (QRIDA) at the Young Beef Producers’ Forum in Roma.
“I originally heard of QRIDA through the Young Beef Producers’ Forum when I would’ve been 18 or 19,“ she said.
“I didn’t really grasp what it was until a few years later when I started being more involved in the financial aspects of the property.“
In 2019, Sarah talked to her local QRIDA regional area manager about securing a First Start Loan to help her fund property projects that would boost the financial viability of her grazing business.
“[The loan] allowed me to put up an exclusion fence around the boundary of the property because we were having a lot of wild dog problems,” she said.
Sarah had recently begun buying paddocks within the farm as part of her family’s succession plan and her calving rate was being impacted by wild dogs.
“I was down eight per cent on my calving rate, which a large chunk was down to wild dogs. The loss of that paid for the interest on the loan to get the fence up so it was a no brainer to do it.”
Building the exclusion fence allowed Sarah to take her beef operation to the next level, expanding into sheep and goats.
“[The fence] allowed me to expand into sheep and go into goats because I can control those enterprises within. It’s been a big benefit to have access to that.”
Sarah found having a local regional area manager to help was beneficial and comforting when applying for the First Start Loan.
“The application process at the time was a little bit daunting. There’s a lot of paperwork in-

volved but once I sat down with the local [QRIDA] representative it was very straightforward.
“When you’re getting started and you’re young, I found it much less confronting if you’re able to sit face to face with someone rather than over the phone.“
Sarah encourages other aspiring producers to

Visit QRIDA at FarmFest Field Days 3 - 5 June, Toowoomba AgSmart Connect Hub (ASI29)
get in touch with their local regional area manager to ask questions about securing financial assistance for their own farming goals.
“Any young ones looking to expand or get into the industry, just go and have a yarn to your local QRIDA representative. Bounce ideas off them and don’t be afraid to jump in, go hard while
you’re young,” she said.
• QRIDA’s First Start Loans offer up to $2 million to help aspiring producers in the initial years of establishing their primary production business.
• For more information on First Start Loans visit qrida.qld.gov.au or get in touch with your local regional area manager on 1800 623 946.
Talk to QRIDA at FarmFest to nd out how our range of grants and low interest loans could help you, including*:
• SustainabilityLoans to help you invest in new and emerging on-farm technologies, improve irrigation systems, establish renewable energy systems, or purchase or upgrade plant and machinery
• FirstStartLoans to help you establish your rst primary production enterprise
• Droughtloansandgrants available to help you prepare, manage, recover and mitigate the impacts of drought.

To nd out more, talk to your Regional Area Manager on 1800 623 946 or scan the QR code to visit our website. *Eligibility


Chasing easy calving, grow fast polled black Angus genetics that perform in the paddock and on the plate? Want to add quality carcase traits and marbling plus extra weight with added feed efficiency?
Be sure to check out this year’s draft of Top of the Range Angus bulls selling 30 May 2025 at the Alumy Creek Angus 2025 Bull Sale Tenterfield held on the NSW/Qld border with 60 x 2yo bulls on offer 1pm Friday 30 May 2025 on property at ‘Coldawinda’ Tenterfield and online with AuctionsPlus.
Since 1987, we’ve focused on producing highperformance stud HBR Angus cattle using the best of global Angus genetics. We have been selling bred Tenterfield tough bulls into Qld since 1992 to a variety of environments from the gulf in the north, west to Charleville plus across Central and Southeast Qld since 1992.
Our quiet, good-tempered, heavy-muscled and easy-fleshing Angus bulls are bred to thrive in real-world commercial conditions. Everyone remarks on how easy our bulls are to handle, how well they work to achieve great pregnancy results and how easy doing they are often coming out of the cows in better condition than they went in.
They sire calves that perform on the ground, in the sale yard and feedlot, and on the plate –because we know our clients get paid on weight, yield, and carcass quality. If you are targeting the domestic or short or long fed feedlot markets, these bulls produce attractive well-muscled progeny that really excel.
Our cow herd breeding philosophy is simple: we focus on the female and select for fertility, sound structure, and longevity – traits that allow our cow herd to thrive unpampered in harsh conditions and raise a calf every year from two years of age, unassisted to add paddock profit and performance. All genetic traits to keep replacement females and build a profit driven herd on.
Sires represented include the first sons of power sire Connealy Big Valley, proven feedlot favourites LT Revered, Mogck Entice and Ferguson Trailblazer and sleep easy heifer performance

sire
sons of the $200K Hoffman Thedford and RR Endeavor. Experience the Alumy Creek difference- 40 years of profit driven performance selected under real world commercial conditions.
These sale bulls are slick coated, paddockreared, vet checked, DNA genomic sire verified, freeze-brand identified and come with full EBVs, 7-in-1, 3-Day, Vibrio, Pestigard vaccinations and
Tested PI negative.
Travelling to or from the 2025 Angus World Forum Expo in Tamworth?
Why not schedule a stopover in Tenterfield to inspect our sale draft? We’d love to have you drop in and take a look!
Bull Inspections available at Coldawinda on May 9th or by appointment. Sale details, videos
and catalogue available online -find us on facebook, our webpage or call Colin or Lisa 0429 431 900 to request a hard copy catalogue in the mail. Joint Agents are George & Fuhrmann Warwick – Matt Grayson 0419 686 540 / Darren Perkins 0428 660 324 and Elders Studstock with Elders Glen Innes – Brian Kennedy 0427 844 047/ Nash Tome 0447 858 693.








Elders FarmFest returns to Toowoomba 3 to 5 June to celebrate its 50th year and, with tickets now on sale, one visitor will win an awesome lucky door prize – a Kubota Z200 42-inch zeroturn mower valued at $10,000, courtesy of Black Truck and Ag.
To secure a chance of winning, visitors need to buy their discounted tickets online at www. farmfest.com.au, saving an extra $5 off the full door price and locking in their experience at Queensland’s largest and most influential agricultural field day.
Serving as a key platform for agribusiness in Toowoomba and beyond, 2025’s milestone event will feature a range of new attractions, as well as more than 2000 exhibitors.
It will showcase cutting-edge machinery, technology, livestock, community services and lifestyle solutions.
Attracting more than 35,000 attendees, FarmFest remains dedicated to supporting farmers and regional communities — connecting industry leaders, innovators and producers in a dynamic, three-day event that drives growth and opportunity across the sector.
This year, visitors from further afield who may not have attended before are being encouraged to make the “day trip“ to see what’s new.
There will also be more prizes on offer at this year’s livestock competition, which will play host to a Brahman feature, alongside the usual FarmFest competition categories such as Battle of the Bulls and Fantastic Females.
Schools will attend with a separate category for students showing cattle. Thanks to the Australian Brahman Breeders’ Association for helping promote this important breed at FarmFest.
For a scrumptious event milestone treat, enjoy a 50th Year FarmFest Meat Pie created by Sonia Hornery from Heartland Grazing Pty Ltd’s Vintage Cow Cafe.
Children of all ages can join in the fun, with the education trail for the little ones, while the older ones can enjoy demonstrations of vehicles, machinery, earthmoving equipment, drones, along with livestock competitions and careerfocused presentations.
Proud sponsors Elders, along with event organisers Australian Community Media (ACM), are promising a field day for everyone – whether it’s a gift from the thriving shopping precinct, Lifestyle Lane or a bargain deal for something new on the farm.
ACM Agri Events general manager Craig Chapman said:
“Whether you’re looking for the best on-farm equipment, the latest in agritech innovation or new kit to keep your property secure - look no further than FarmFest,“ he said.
“With more than 2000 products and services on offer, along with field day special offers, you’ll be best placed to secure the right product at the




right price.”
Mr Chapman said five decades of success were the result of incredible sponsors and partners who have helped build the field day year after year.
“The list of industry leaders who make FarmFest such a brilliant event is a credit to their own businesses.
“From machinery dealerships like Hastings Deering and Engage Ag and our vehicle partners
Toowoomba Mahindra and Black Toyota, we’ve got every product available whether it’s new



fencing from Clipex or an array from farming products from Dalby Rural Supplies, it’s Australia’s best one-stop shop for farmers.”
Elders state general manager for Queensland and the Northern Territory Lisa Hewitt said as Queensland’s largest and most successful annual field day, Elders FarmFest continued to be a cornerstone of the agricultural calendar.
“In 2025, we’re proud to add even more value for attendees,“ she said.
“Elders is hosting a range of engaging events and workshops in our iconic big red Elders tent,
including a next generation breakfast, an education roadshow and workshops on renewable energy, biodiversity, carbon farming, succession planning and financial solutions.
“We are really looking forward to connecting with our clients, showcasing the latest innovations and continuing to support the future of primary industries.
“We look forward to having everyone along to celebrate 50 years of Elders FarmFest and welcome all attendees to the Elders site for a free coffee and a chat with our friendly team of agricultural experts.“











New competition classes and double the prize money for the prestigious Paddock to Palate Wagyu Challenge at the Royal Queensland Show are expected to attract record entries.
Entries for the 2026 competition opened last month, with the Wagyu Challenge regarded as one of the world’s most commercially relevant beef competitions as it allows producers to benchmark their cattle and gain insights through industry-leading data collection.
The most significant change is the addition of two classes to the competition instead of one: Fullblood/Purebred (with genetics above 93 per cent Wagyu) and Crossbred (with genetics below 92pc Wagyu).
RNA Beef Committee chair Gary Noller said the change was made to ensure a fairer competition between different genetic classifications.
“Crossbred Wagyu will always gain faster and feature in the weight gain phase, while fullblood cattle perform better in carcass judging,“ he said.
“So, by splitting the Wagyu Challenge into two classes we make it a more even and fair competition.
“This change also means the overall prize pool has doubled to $18,000, providing more producers with the opportunity to share in the rewards.”
Another important change is that JBS Australia will buy all competition entries as feeder steers. This will give exhibitors a competitive rate when they enter the feedlot rather than when the competition ends.
This eliminates the risk associated with fluctuations in feed and grid prices, giving producers more financial certainty.
As part of the revamp, steers will also be fed at the JBS Beef City Feedlot west of Toowoomba for the first time, for a shorter period of 380 days, before being processed at the Beef City Plant.
RNA Beef Committee chair Gary Noller said shifts in the commercial environment and consumer expectations drove the changes, including the reduced time on feed.
“This revamp is about aligning the competi-

tion with current industry standards and ensuring it continues to be relevant for producers and consumers,” he said.
“The changes to the competition are all very positive and, as a result, we’re expecting to see an increase in the number of entries this year.”
you have a story to tell,
The competition features four phases: weight gain, a carcass competition, carcass value and a beef taste off.
The exhibitor who polls the highest aggregate score across all four phases will be awarded the overall prize at the Paddock to Palate Awards and
producers to benchmark their cattle and
Beef Industry Dinner during Ekka Beef Week in August 2026.
Deadline for entries is 2 May, 2025.
• Please visit www.ekka.com.au/animal-experiences/beef-cattle/paddock-to-palate for entry details.

Fiona Gowers | E: fiona.gowers@queenslandfarmertoday.com.au For all your classified and advertising enquiries, contact our team.
Jane Lowe 0408 488 609
E: jane.lowe@queenslandfarmertoday.com.au
Daniel Pelcl 0408 956 830
E: daniel.pelcl@burnetttoday.com.au
Sharon Jones
P: 07 4182 0451
E: sharon.jones@burnetttoday.com.au
Edition out on May 30, 2025
40,000 readership per month
Inserted into the following newspapers:
• South Burnett Today
• Central & North Burnett Today
• Warwick Today
• Stanthorpe Today
• Leader Today
• Jimboomba Today
• Beaudesert Times
• Emerald Today
• CQ Today
• Goondiwindi Argus
Also available from the follow outlets:
• Hartleys Newsexpress Toowoomba
• Roma Sale Yards
• Warwick Sale Yards
• Highfields News & Post
• Pittsworth Newsagency
• News Extra Central City
• Dalby Saleyards
• The Barn, Oakey
• Crows Nest Newsagency
• CQLX Gracemere,
• Longreach saleyards
• Emerald saleyards
• Meringandan Produce
• Goombungee Newsagency

Report Date: 16/04/2025
Saleyard: Casino
There was a small yarding of 490 head consisting mainly of weaners and cows. Quality of the young cattle was very mixed with increased numbers of lighter weaners through the sale. Not all the usual buyers were present.
The wide range of prices was an indication of the variation in quality. The better bred weaner steers attracted the keenest interest. Restocker weaner steers sold from 322c to 430c to average 390c/kg. Restocker weaner heifers ranged from 236c to 338c/kg. Feeder and restocker yearling steers toped at 395c/kg.
There was only a few pens of grown steers, the top price was 354c, while grown heifers reached a top price of 349c/kg. The cow market was easier with 3 and 4 scores selling from 270c to 295c/kg. Doug Robson Reporter.
Report Date: 23/04/2025
Saleyard: Dalby
The short working weeks continued to disrupt the supply of cattle into Dalby with numbers falling by another 1,778 head to 2,294. A single consignment of 368 head from Goondiwindi and 133 head from New South Wales were included in the lineup. A full panel of export buyers was present however not all were operating. The regular feed and restocker buyers were in attendance and operating.
Light weight yearling steers under 280kg to restockers experienced only quality related price changes while the under 330kg lines averaged 9c/ kg better. Yearling steers to feed were firm to 10c/ kg dearer. Light weight yearling heifers to restockers improved in price by 8c/kg. Heavy weight yearling heifers to feed lifted in price by a similar amount. Cows sold to within 2c/kg of the previous sale.
Light weight yearling steers returning to the paddock made to 492c to average 431c/kg. Yearling steers to feed for the domestic market averaged from 405c to 414c with sales to 440c/kg. Heavy weight yearling steers to feed averaged 390c and made to the occasional 424c/kg. Light weight yearling heifers to restockers averaged 338c and made to 358c/kg. Medium weight yearling heifers to feed made to 386c to average 352c and heavy weights averaged 359c and made to 380c/kg.
The occasional bullock made to 366c and heavy grown heifers to export processors made to 346c/kg. Medium weight 3 score cows averaged 284c and made to 291c/kg. Heavy weight 3 score cows averaged 286c and the best of the heavy weight cows made to 310c to average 304c/ kg. Heavy weight bulls made to 336c/kg. Market Reporter, Trevor Hess.
Report Date: 22/04/2025
Saleyard: Roma
Owing to the Easter weekend and short weeks Roma Agents yarded 2,680 head. All the regular processors feedlotters and backgrounders present. Once again a quality yarding penned. The market improved for all descriptions.
Yearling steers under 200kg topped 422c/ kg. Yearling steers 200 to 280kg sold from 300c to 468c/kg. Yearling steers 280 to 330kg also im-

proved topping 478c/kg. Yearling steers 330 to 400kg made to 435c to average 390c/kg to feed. Yearling steers 400 to 480kg with the majority making to 402c/kg.
Yearling heifers under 200kg topped 274c/ kg. Yearling heifers 200 to 280kg improved by as much as 30c/kg to make 384c to restockers and 306c/kg to processors. Yearling heifers 280 to 330kg also improved and sold to 312c/kg. Yearling heifers 330 to 400kg sold from 320c to 366c/ kg to restockers. Yearling heifers 400 to 480kg made from 320c to 360c/kg.
Grown steers 400 to 500kg made to 370c/kg. A small number of bullocks sold and made 360c/ kg to processors. Only a small number of of cows penned. The 2 score cows sold from 200c to 286c/ kg. The 3 score cows over 520kg topped 310c/ kg. Bulls up to 450kg sold to 334c/kg to restock-
ers. Bulls over 600kg lost ground on last sale and made to 316c/kg. Cows & calves sold from $920/ unit to $1910/unit. Market Reporter David Friend.
Report Date: 22/04/2025
Saleyard: Warwick
The supply of stock at Warwick reduced to 694 head of mainly weaner vealers and yearling cattle with only a small sample of bullocks, cows and heavy feeder lines which sold firm to slightly easier prices depending on type and quality. All the regular export buyers attended however with the smaller yarding not all operated the feeder and restocker buyer attendance increased.
Vealer steers to background made 438c to average 401c/kg. Yearling steers in the 200-280kg range to restockers sold to 420c and averaged 374c/kg. Yearling steers to feed for the domestic market made 380c to average 358c/kg. Heavy
yearling steers to feed averaged 370c and sold to 382c/kg with those to the wholesale meat trade at 396c/kg. Vealers heifers to restockers made 318c/ kg. Lightweight yearling heifers to background made 380c to average 326c/kg. Yearling heifers in the 200-280kg range to processors made 334c to average 313c/kg. Medium weight yearling heifers to feed made 376c to average 336c/kg. Grown steers to feed sold to 380c and averaged 376c/kg. Grown heifers to processors sold to 335c/kg. Light weight 2 score cows to processors improved by 6c and sold to 269c/kg. Heavy score 3 cows to processors made 285c to average 278c with the best heavy cows at 308c to average 295c/ kg. Light weight bulls to restockers made 340c to average 335c/kg. Heavy bulls to processors made 323c to average 309c/kg. Market Reporter Errol Luck.







































Federal Member for Flynn Colin Boyce has announced an elected LNP Government would provide $1 million to the Gracemere Junior Rugby League (JRL) Football Club.
Mr Boyce said the election commitment would go towards upgrading lighting infrastructure at the Gracemere JRL ground, which forms part of the club’s master plan.
“The master plan aims to upgrade the club’s facilities to meet the growing needs of its members and the community,” Mr Boyce said.
“It is designed to enhance the sporting experience, increase participation rates and foster community engagement.
“It focuses on creating a safe, inclusive and
well-equipped environment that can support the club’s growth and provide a central hub for various sporting and community activities in the Gracemere area.
“The upgraded lighting is expected to attract more members and is part of the club achieving long-term financial sustainability as well as positioning it as a cornerstone of local sports and recreation.
“Gracemere has been identified as one of the fastest growing communities with about 13,000 people currently calling it home.
“Today’s announcement is a key part of making sure that Gracemere has the infrastructure it needs well into the future.”
Men and women’s football in Gladstone will continue to grow under an elected LNP Government, with Federal Member for Flynn, Colin Boyce announcing $320,000 for the Central Football Club and $400,000 for the Clinton Park Sports Association.
Mr Boyce said the funding would provide inclusive and accessible facilities that cater for the diversity of participants, particularly females, who wish to participate in the game.
“The current change rooms at Central Football Club are very old and no longer fit for purpose, given the number of players that the club now has and in particular women and
girls,” Mr Boyce said.
“Currently, females are changing in the hallway, as there is no room in the change area.
“The funding for the Clinton Park Sports Association will construct a new amenities building including a female-friendly change room, toilets, umpire facilities and first aid room.
“If we want to support female participation, we need to back our local sporting clubs with investment and that is what these upgrades will do.”

Australia’s fiercest sporting rivalry is again saddling up – but this ain’t footy!
This is bull riding Origin - PBR-style - and in 2025, it’s tougher, louder, and prouder than ever.
The PBR Monster Energy Origin Series is back, storming into Newcastle, Brisbane and Sydney for a three-round battle of epic proportions. And the teams? They’re now locked, loaded and ready to ride.
The PBR Australia Origin Series is an electrifying state-versus-state bull riding competition, where top riders from New South Wales and Queensland face off in a thrilling trio of events.
Modelled after the State of Origin rugby series, the Origin Series has quickly become one of the most anticipated highlights of the Professional Bull Riders Australia (PBRA) tour since its debut in 2019.
As a central feature of the PBRA’s annual schedule, which includes over 20 events nationwide, the PBR Origin Series plays a vital role in elevating bull riding in Australia.
It also serves as an important pathway for emerging riders to progress to the international stage, further solidifying the series as a key part of PBRA’s commitment to growing the sport.
PBR Australia managing director Glen Young said the fiercest rivalry in Australian sport isn’t just played out on the footy field—it rages in the rodeo arena too.
“Welcome to the PBR Monster Energy Origin Series, where the boys go head-to-head in the toughest test of skill, strength, and sheer grit: professional bull riding,“ he said.
“With nothing but eight seconds standing between glory and the dust, these boys ride for more than just personal victory—they ride for state pride.
“Queensland hasn’t lost an Origin Series since it began in 2019, so this year, it’s going to be a fierce battle, with Queensland pumped for back-to-back victories, and NSW keen to make their mark.“
Team Queensland line up:
• Kurt Shephard – Mareeba’s finest, and current PBR Australia leaderboard leader
• Macaulie Leather – Calliope’s cowboy dynamo
• Ben Bode – Leather’s Calliope counterpart, all grit and grind
• Thomas Triplett – Bungandarra’s bull-taming machine
• Bryn Francis – From Moura, riding with fire in his veins
• Caiden Sandilands – Rocky’s own rising star
• Zane Hall – Athol’s adrenaline-chaser
• Jack Keats – Cloncurry’s cool and calculated charger
• Rylee Ward – The Kiwi connection, adding international edge to QLD’s dominance
• Nash Mellors – The Gracemere young gun with ice in his veins.
• With Bowen’s Beau Willis and Brumby Brandenberg from Bloomsbury the two reserves Team New South Wales team list:
• Jack Brodrick – Bungendore’s bold frontrunner
• Tyson Smith – The pride of Walcha
• Jack Rowlandson – Oberon’s steel-nerved slinger
• Dylan Weir – Tumut’s determined force
• Clint Glass – The quiet powerhouse from the NSW Liverpool Plains (Willow Tree)
• Toby Adams – From Mendooran, fierce and focused
• Lauchlan Waters and Wyatt Fraser from South Australia join the Blues in battle
Four Brazilian stars join the charge as international bull riding warriors ready to shake things up: Joao Rigaard Franco, Matheus Lima Rodrigues, Luan Crystian Camara, and Diego Galdino.
Origin line-up:
• Origin one - held at the Newcastle Entertainment Centre on Saturday, 3 May at 7pm.
• Origin two - held at the Brisbane Entertainment Centre on Saturday, 7 June at 7pm.
• Origin three - held at the ICC Sydney Theatre on Saturday, 5 July at 7pm.
Meet the coaches
Coaching Queensland is bull rider-turned one of the toughest Protection Athletes in the game Jared Borghero for Queensland, and behind NSW is seven-time PBR World Finals qualifier and one of the sport’s most respected competitors in Gresford-


born Lachie Richardson.
Twice national champion, Singleton’s Cody Heffernan is assisting Richardson.
Queensland coach Jared Borghero
Born and bred in Beaudesert, Queensland Origin coachJaredBorgherohasspenthislifeinthedirt— first as a bull rider, then as one of the toughest Protection Athletes in the game.
Bull riding runs deep in the Borghero family— four generations deep.
At 15, he rode his first bull, by 2016-17 he won the legendary Mount Isa Rodeo bull ride, securing the APRA Pro Tour title, and earning Protection Athlete of the Year—a season he’ll never forget. It was in 2015 that he found his true calling—becom-

ing a PBR Protection Athlete.
With 13 Protection Athlete titles, he’s built a legacy of fearlessness and instinct.
“It’s one of the top three proudest moments of my life to be appointed coach.”
His philosophy? Queenslanders don’t just compete—they dominate.
“We are all one in the maroon sheds. We support each other, we fight for each other, and I have no doubt these boys will make Queensland proud again,“ he said.
“My advice is to get comfortable with being uncomfortable.”
New South Wales coach Lachie Richardson
From the rolling hills of Gresford, NSW, to the
world’s biggest bull riding stages, the New South Wales coach Lachie Richardson has built a career defined by toughness.
A seven-time PBR World Finals qualifier, the 2012 PBR Australia Rookie of the Year, and one of the sport’s most respected competitors, now, he steps into a new challenge—leading Team New South Wales.
Lachie was just 10 years old when he rode his first calf, and his crowning moment?
Qualifying seven times for the PBR World Finals, the pinnacle of professional bull riding. His game plan?
Letthetalentshinewhileensuringhisridersare mentally strong and ready to perform. “We don’t talk. We ride. Rest at the end, not in the middle.“


By Maddison Richards
The recently established South Burnett Quarter Horse Cutters Inc. have held their first successful clinic.
On Saturday, 5 April at the Murgon Showgrounds, the club held their first cutting clinic, structured for beginners to understand the basics and fundamentals of cutting.
The clinic was aimed towards those just stepping foot into the world of cutting, to provide a stress free learning environment, as the club saw this type of learning was lacking in the area.
“Just having the opportunity to practise,” Head of Marketing and Media, Maggie Cowan said. “That’s the biggest thing.”
“When you have cutting days, there’s no opportunity to actually understand what cutting is, what the rules are,” she said. “That’s the aim of today, an introduction to cutting.”
“Being able to facilitate an opportunity for people to come and practise on cattle and have a better understanding of the rules of cutting,” was the inspiration behind holding this beginners clinic.
With the clinic being completely booked out, the clinic was deemed a success.
As soon as it was announced the club would be holding a clinic, there was a huge amount of interest from the community.
Keeping numbers limited to ensure the best quality of the clinic, with visiting expert Lisa Gibbson volunteering her time and skills, the turn out was awesome, with many people through social media inquiring about the possibility of future clinics.
Participants of the clinic walked away with a better understanding of the fundamentals of cutting, the rules of cutting and a new perspective as a whole of what cutting is for both horse and rider.
“Understanding the rules of cutting and how to start your horse with the basics,” Maggie said. “Being able to read a cow and position your horse, where you should be during your cutting.”
“Stripping everything back to basics and starting to understand what cutting is and what you’re supposed to do once you get in the pen,” she said.
The clinic was structured to provide a place where beginners could learn in a safe environment without the stress and pressure of it being a comp day and being thrown in the deep end.
Holding clinics similar to this is important, as it provides a safe space for beginners to learn at their pace, and allows the younger generation to become interested and learn the basics of cutting before being thrown into the pressure of Point Days.
“It’s important to provide a space like that, so that people feel more comfortable to come to points days later down the track,” Maggie said. “It gives people a little bit more opportunity for that community sense. Just being able to be around people in the cutting industry.”
Since the club formed last year, it has received a huge amount of interest from the community.
“Whilst there are other cutting clubs around the wide bay, it’s just a lot closer for a lot of people in this area,” Maggie said.
With nowhere else to go but up, the club aims to provide more clinics for beginners, as they are very guided by what the people want.
Through social media, the club gauges what the people need in terms of cutting, and aims to fill these needs.
“Providing more clinics for beginners and be-


ing able to give people the opportunity to practise on cows without having that pressure of a show or points day,” is a goal of the club, Maggie said.
“Continue building the community around the cutting club, so people are feeling welcome,” was another.
The club hopes that by holding clinics designed for beginners, whether it be the younger generations or people looking to transition from campdrafting and gain new understandings, they can provide useful resources to the cutting community and foster a supportive environment for beginners.


The Toowoomba Showgrounds will host the 2032 Olympic and Paralympic Games Equestrian events.
Toowoomba mayor Geoff McDonald said the $54 million Toowoomba Equestrian Centre was a legacy project that would benefit Queenslanders for the next 50 years.
“This is a watershed moment for the Toowoomba region,” mayor McDonald said.
“We are jumping for joy today.
“Our advocacy efforts … have paid off. In addition to the legacy element, to play such a significant role in the delivery of the world’s largest event, the Olympic and Paralympic Games in 2032, is a coming-of-age moment for the Toowoomba region.
“What an exciting time it will be for Toowoomba to have Olympic medals awarded right here in our region.
“The eyes of the world will be on us as the best dressage, showjumping and eventing riders and their incredible horses compete for Olympic glory right here in Toowoomba.
“The flow-on effects of today’s announcement could be massive and lead to the delivery of infrastructure for our region that may not have been possible without the golden opportunity of hosting Olympic and Paralympic events.
“I congratulate all involved in putting forward the Toowoomba Equestrian Centre project including the Royal Agricultural Society of Queensland (RASQ), Toowoomba and Surat Basin Enterprise (TSBE) and commend the Queensland State Government for realising the legacy benefits to come as a result of today’s announcement.”
Speaking from the Glenvale Room at the Toowoomba Showgrounds, Queensland Treasurer and Member for Toowoomba South David Janetzki said it was a privilege to be at the centre of the decision that brought the Olympics to Toowoomba.
“This is more than a couple of weeks of sport, this is a lasting legacy for our region for decades to come,” he said.
TSBE has worked with the RASQ for about four years on the notion and plan to upgrade facili-
ties at the Toowoomba Showgrounds to provide world-class horse sports facilities.
The Toowoomba Equestrian Centre (TEC) will capitalise on Toowoomba Showgrounds and Event Centre’s existing equestrian facilities.
RASQ CEO Damon Phillips said the project would leave the region with an equestrian centre capable of delivering national and international level events for a wide range of disciplines, including the Olympic equestrian sports.
“This facility will transform equestrianism in Queensland and will be generationally meaningful for the Toowoomba Showgrounds,” he said.
The nationally-significant project aims to fill identified state and national gaps in equestrian facility provision.
In Queensland, there are currently no competition facilities with international-level equestrian surfaces.
Across Australia, there are very few facilities of sufficient scale and quality to host national equestrian championships. Filling this demand will keep talent and competition in Queensland and grow the equestrian industry and support athlete pathways.
The economic benefits generated by the TEC include the economic contribution from a growth in service delivery, participation in equestrian sports, new markets and the sports tourism benefits from resulting visitation, as well as postconstruction employment. These benefits extend well beyond the project construction phase. Once completed, the cost-benefit analysis indicates that the added value to the Toowoomba economy over the first five years will be in the vicinity of $6.8 million annually.
Mark Mason, TSBE’s Olympics Strategy project manager said the region had significant local capability and capacity to do the heavy lifting for both the development of the infrastructure build and the delivery of The Games.
“We, as a region, have worked very hard together to bring this vision to life and we look forward to meeting with the key stakeholders in the coming days and weeks to chart a course that delivers the best possible outcomes for our region and Queensland as a whole, Mr Mason said.”

By John Salvado/AAP
Big Matt Denny has capped the best week of his sporting life by bettering the discus world record - only to again have to play second fiddle to Lithuanian powerhouse Mykolas Alekna.
Three times in the space of seven days in the United States, Olympic bronze medallist Denny has smashed his personal best.
The pick of those efforts was the 74.78m the 28-year-old Queenslander managed at the Oklahoma Throws Series World Invitational on Sunday 13 April in Ramona, a venue beloved by throwers due to the gusty conditions and favourable tailwinds.
That was better than the 74.35m which Ale-



kna managed at the same event last year to break a world mark that had stood untouched since 1986.
The only problem for Denny was that Olympic silver medallist Alekna, 22, went even better on Sunday with monster heaves of 74.89m on his opening throw and 75.56m in the fourth round.
Even so, Denny has enjoyed a remarkable week in the US, more than justifying his decision to skip the Australian championships in Perth.
He finally crashed through the 70-metre barrier for the first time last weekend with 72.07m and improved that PB again with 74.25m three days ago, also in Oklahoma.


Denny has claimed gold at the past two Diamond League finals, bronze at the Paris Olympics and finished in the top six at the three most recent editions of the world championships.
He will be among Australia’s leading goldmedal hopes at September’s world titles in Tokyo.
Matthew
the Adelaide Invitational. (AAP Image/Michael Errey)

